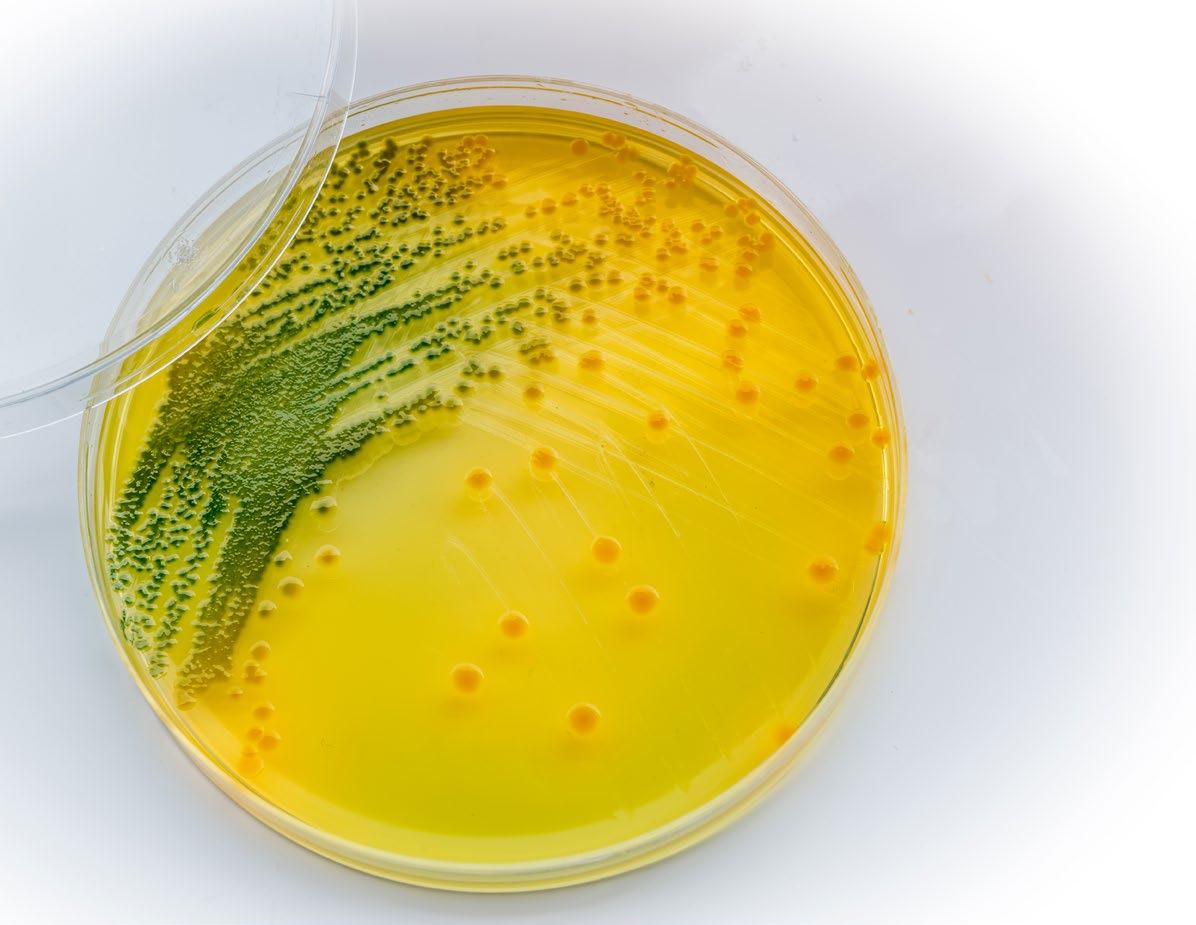

Market Opportunities for U.S. Aquaculture Producers: The Case of Branzino.
Restorative aquaculture: a way forward for sea urchins in the Mediterranean.























Market Opportunities for U.S. Aquaculture Producers: The Case of Branzino.
Restorative aquaculture: a way forward for sea urchins in the Mediterranean.
Toward an environmentally responsible offshore aquaculture industry in the United States: Ecological risks, remedies, and knowledge gaps.
Superior protection with the new Green Pin® Aquaculture range.
Editor and Publisher
Salvador Meza info@dpinternationalinc.com
Collecting demographic data for the EU aquaculture sector: What can we learn?
Application of hybrid electrocoagulation–filtration methods in the pretreatment of marine aquaculture wastewater.
Dietary mannan oligosaccharides positively affect the growth, digestive enzyme activity, immunity and resistance against Vibrio harveyi of Pacific White Shrimp (Litopenaeus vannamei) larvae.
Supporting the aquaculture of the world’s largest archipelago (Indonesia).
Contributing Editor Marco Linné Unzueta
Editorial Coordinator Karelys Osta edicion@dpinternationalinc.com
Editorial Design Perla Neri design@design-publications.com
Designers
Rozana Bentos Pereira
Sales & Marketing Coordinator
Juan Carlos Elizalde crm@dpinternationalinc.com
Marketing & Corporate Sales Abril Fernández sse@dpinternationalinc.com
Operations Coordination Johana Freire opm@dpinternationalinc.com
Business Operations Manager Adriana Zayas administracion@design-publications.com
Subscriptions: iwantasubscription@dpinternationalinc.com
Design Publications International Inc. 401 E Sonterra Blvd. Sté. 375 San Antonio, TX. 78258 info@dpintertnatinonalinc.com Office: +210 5043642
Aquaculture Student Conference.
Office in Mexico: (+52) (33) 8000 0578 - Ext: 8578 Aquaculture Magazine (ISSN 0199-1388) is published bimontly, by Design Publications International Inc. All rights reserved. www.aquaculturemag.com Follow us:
 Stephen G. Newman Ph.D. * President and CEO, AquaInTech Inc.
Stephen G. Newman Ph.D. * President and CEO, AquaInTech Inc.



Much has been said that in order to ensure the necessary aquaculture production and its sustainability, multidisciplinary and inter-institutional research (R+D+i) must be the driving force that, in the coming years, will increasingly supply food from the ocean and fresh water, implying that aquaculture will be continuously and constantly promoted as a source of food, as long as it is recognized as a primary activity and National Security.
This is due to the continuous overexploitation of marine and inland water resources, which allow populations, both coastal and in their distribution chain, to maintain their economic level and food supply; however, it has been observed that if this situation continues, without taking into account good production practices in a sustainable manner, it could lead to the collapse of fisheries that, unfortunately, have reached critical levels, putting at risk the conservation of populations of various species of commercial inter-
est and accelerating a serious loss of biodiversity.
One of the aquaculture activities of special relevance is aquaculture, and there is a great need to diversify the types of culture and the species cultivated. Therefore, R+D+i efforts should be focused on generating more information concerning mariculture, a relatively new activity of great importance at the international level, especially if it is intended to be carried out in new sites where previous studies are required before carrying out a productive activity. The main limitations of the activity have been the lack of information and inputs for its generation. On the other hand, there is skepticism about the functioning of the activity on the part of the authorities.
Sustainable and competitive aquaculture must overcome numerous technical, regulatory and economic barriers to innovation and business development and, although the major challenges are technological innovation and measurement needs, the enabling environment - includ-
ing regulatory simplification and stability, the availability of investment capital for aquaculture enterprises and the overall policy environmentmust be considered for the successful development of aquaculture.
To this purpose, it is vital to identify the areas of opportunity for the development of aquaculture production, oriented to cut the most critical gaps, whose solutions can lead to the improvement of competitiveness and large-scale development of the aquaculture industry in the world. For the consolidation of aquaculture in the country, it is important the alliance of the productive, government and academic sectors, in order to build scenarios of greater competitiveness of the sector, which respond to international trends and demands regarding the development of a sustainable aquaculture, which considers the balance between the profitability of the activity, the generation of jobs, the attraction of foreign exchange, food security and environmental conservation.

Aker BioMarine, in partnership with LetSea and Nofima, submitted its application to the Norwegian Directorate of Fisheries to conduct research within salmon farming and aquafeed. The goal is to increase the share of krill and other raw materials used in fish feed formulations today, and shed light on new opportunities within the ingredients, aquafeed, and aquaculture industry.
By applying for research permits, Aker BioMarine will help pave the way for new, sustainable raw materials. Together, the three companies plan to evaluate the performance of krill, as well as other, new raw material ingredients, when included in the fish feed.
“If we receive approval, we plan to test seven new raw materials within seven years, with the goal of increasing the combination of new raw materials in fish feed from 0.4 percent to 25 percent by 2030,” said Matts Johansen, CEO Aker BioMa-
rine, during a panel discussion at the Bellona ‘Raw Materials Pledge’ event.
Aker BioMarine aims to bring its knowledge and experience to a new, large-scale research trial, to be conducted in collaboration with LetSea, the experimental and research center for aquaculture, along with the research institution Nofima. Their joint project has been named the “Raw Material Revolution”, a name that signifies the urgent need for more sustainable ingredients in a rapidly growing aquaculture industry.
“The role of the raw material suppliers, including Aker BioMarine, has been passive until now, especially during large-scale trials conducted under real farming conditions, even when our own raw materials have been used in fish feed. This project
differs from other studies in that we want to focus on the importance of raw materials in the final feed formulation and evaluate a combination of new raw materials. With this project, we are now taking a much more active role by running our own large-scale research,” explained Johansen.
Since 2006, Aker BioMarine has harvested, processed, marketed, and sold krill products as an ingredient in fish and animal feed, in addition to omega-3 supplements for humans. Today the company has a separate department dedicated to research and development which consists of 15 employees with PhDs who have published more than 200 scientific articles.
“Refining a new ingredient and introducing it to the market is both expensive and time-consuming. Aker BioMarine spent 15 years researching and documenting the effects of krill alone. The aquaculture industry

needs to see much faster development,” assured Johansen.
“With research permits from the Norwegian Directorate of Fisheries, it is possible to carry out necessary and important research that will help us mitigate future risk related to sustainability within aquaculture. The approval for this research is a green light for us to increase our knowledge and stimulate greater sustainable growth across the industry,” he added.
As part of the research collaboration, Aker BioMarine, Nofima and LetSea will each contribute with their own expertise and experience, stemming from across the industry and through previous studies. Together, the companies aim to produce robust documentation of new and sustainable feed.
Nofima, who will hold the scientific responsibility within this re -
search project, has a long track record of conducting research within the aquaculture and fisheries industries, among other areas. For several years, Nofima has worked to document new, sustainable ingredients for salmon feed on both a small and large scale.

“The industry wants to use a greater amount of new, sustainable ingredients, and we need to move quickly to do so. Large-scale research is a necessary tool for success, and we have the knowledge and set-up required to contribute to the development of new raw materials for feed,” says Bente Torstensen, Division Director at Nofima.
LetSea is Norway’s largest privately owned research facility center for aquaculture, and has among other things, farmed salmon in trials.
“It’s no coincidence that this project will take place in Helgeland at LetSea. We have worked with research in multiple areas, every day,
since 2001. If the industry is to succeed, we are dependent on driving these kinds of initiatives,” says Henriette Hanssen, R&D Director at LetSea.
Norway has an ambition to more than triple the production of salmon and trout by 2050, at the same time the government has set a target that all fish feed in Norway must be from sustainable sources by 2030. To achieve sustainable growth in seafood production, the Norwegian aquaculture industry must quickly ramp up the use of new raw materials in aquafeed. Currently, Aker BioMarine is one of few global players that has successfully introduced and scaled a new raw material, Antarctic krill, from idea to more than 50,000 tonnes of ingredients produced annually.
The Raw Materials Pledge is a movement within the Norwegian seafood industry to stimulate greater diversity and sustainability in aquafeed raw materials. The companies that have pledged support include Aker BioMarine, Skretting, Lerøy and Sjømat Norway – headed by Bellona. The shared ambition is to increase knowledge and awareness about new raw materials. Together, the group presented their report on this topic to the Minister of Fisheries and Ocean Policy, Bjørnar Skjæran, during the Bellona event.
Atarraya, the company behind Shrimpbox, the first plug-and-play sustainable shrimp farming technology, and BiomEdit, a microbiome innovator focused on animal health, announced a collaboration agreement a few days ago to investigate microbial changes to improve the sustainability and production associated with shrimp farming. Ultimately, the goal is to significantly improve the profitability of sustainable shrimp aquaculture, as feed is responsible for about 50% of the cost of production of the species.
The research partnership will focus on the control of nitrifying microbes and vibriosis, and will study how microbial communities change over time in a shrimp biofloc system to define the ecosystem homeostasis created for sustainable shrimp farming. The knowledge gained from the study will help minimize water use, improve the environmental footprint of production and reduce the amount of feed needed to produce shrimp.
The results of this research project will help Atarraya increase shrimp production while reducing costs and improving sustainability. Together, we are making shrimp the most sustainable protein option in global food production, said Daniel Russek, CEO and founder of Atarraya.

The goal of the Atarraya and BiomEdit research collaboration, the companies reported, is to gain a better understanding of microbial communities and their correlation with nitrogen spikes and other environmental changes. Our collabo -
ration with BiomEdit goes back to Atarraya’s core idea: to use deep scientific insights to optimize protein production and contribute to global food security, added Russek
Atarraya and BiomEdit hope to learn more about the ecosystem in aquaculture by using advanced microbiological tools to analyze the composition and diversity of microorganisms inhabiting the shrimp pond, as well as their interactions with each other and their environment.
The Microbiome project will enable a deeper understanding of the
role of the microbial community in maintaining culture homeostasis, explains André Freitas, director of Biotechnology at Atarraya. The future of modern aquaculture is based on the use of innovative technology applied to high productivity systems, rational use of water and production of premium quality proteins. Shrimp farming in a biofloc system is the face of this new aquaculture.
Atarraya’s shrimp farming technology uses biofloc technology to transform waste nutrients into feed with the help of microorganisms.
As part of the research collaboration, BiomEdit will use its genetic sequencing platform to provide critical information on the functions of various microorganisms in the shrimp growth cycle through high-throughput strain isolation and characterization.
The approach is especially critical in land-based aquaculture systems with low environmental impact and increases the reliability of shrimp protein production. The research results will be used to inspire strategies to optimize the health and performance of aquaculture shrimp production.
It is worth noting that, as one of the world’s most popular proteins, shrimp plays a key role in feeding a growing world population. In the last five years, shrimp sales volume increased from 275 to 415 million pounds. However, according to Atarraya’s vision, conventional shrimp farming methods are disastrous for the environment: they destroy the seabed and pollute the oceans.
In that sense, Aaron Schacht, CEO of BiomEdit, said: “We are pleased to collaborate with Atarraya to find new ways to unlock the potential of the microbiome for shrimp farmers who are trying to increase production and reduce their environmental footprint to meet the demands of a growing population. Our deep knowledge of the microbiome in livestock combined with Atarraya’s immense experience in shrimp production systems and aquaculture form an ideal combination to optimize the use of the biofloc”.
For the entrepreneurs, housed in a traditional shipping container, Shrimpbox by Atarraya is the key to meeting the growing demand for shrimp by increasing production while minimizing the impact on the planet.

Based in Mexico City and Indianapolis, Atarraya is on a mission to make shrimp the sustainable protein of the 21st century. Powered by AI, Atarraya’s proprietary Shrimpbox is a true “plug and play” sustainable shrimp farm to transform aquaculture through the use of the most advanced biotechnology, software and hardware available.
Atarraya’s Shrimpbox technology was developed over the past 10 years by a team of engineers, biologists and developers from Mexico, Norway, Brazil, Argentina and Poland. Atarraya’s holdings -a private corporation backed by Jeffrey Hor-
ing, Mark K. Gormley and other angel investors- include Maricultura Vigas, a sustainable aquaculture production company with a decade of experience in shrimp farming using biofloc technology that minimizes water use and eliminates the need for antibiotics and harmful chemicals.
As for BiomEdit, founded in 2022 and based in Fishers, Indiana (USA), it is a company dedicated to discovering, designing and developing novel probiotics, microbiomederived bioactives and microbial medicines to meet animal health needs. The company is partnering with Ginkgo Bioworks to amplify and accelerate product discovery and development with the goal of introducing innovation in livestock and veterinary production. BiomEdit is Microbiome Innovation in Animal Health.

Last October 24 started a series of seminars that broadcasted findings from a world-leading academic study assessing potential health risks associated with nanoparticles found within the Atlantic aquaculture industry. The ground-breaking NanoCulture Project has been funded by the Interreg Atlantic Area, via the European Regional Development Fund (ERDF).
The NanoCulture project has brought together world leading aquaculture professionals, analytical chemists, physical chemists and molecular biologists. Working in collaboration they have developed sensors to detect the presence of engineered metallic nanoparticles in aquaculture. These sensors are able to monitor the levels of exposure to nanoparticles in seawater across aquaculture specimens, in order to assess their impact on human intake.
“We look forward to embarking on the next phase of the NanoCulture project, involving open discourse with industry colleagues to explain the key findings of our studies,” said Project Coordinator, Begoña Espiña. “The online webinar series is being hosted by key partners, and staged in a variety of languages, to maximize accessibility and broaden the reach of our communication. We invite all interest parties to register at the earliest convenience,” she added.
Project coordinator said the online seminars divulged knowledge about a relatively unknown subject to global audiences, in a bid to drive improvements and sustainability for the fastgrowing sector.
“In recent years nanoparticles have been increasingly used across a diverse range of industrial appli-
cations,” said Ms. Espiña. “However, limited scientific research has been conducted to assess the toxicity of nanoparticles, and the potential knock-on effect to the human system. Given the importance of the aquaculture sector for the Atlantic Area, the NanoCulture research group has set about extensive studies. This will enable us to better understand possible adverse effects and in turn improve the safety of future food production and any environmental-related impacts of the activity.”
The international collaboration has involved International Iberian Nanotechnology Laboratory (INL) and the Centro Interdisciplinar de Investigação Marinha e Ambiental (CIIMAR) located in Portugal, alongside Indigo Rock Marine Research Station from Ireland, the University of Vigo, the University of Santiago de Compostela (USC) and Centro Tecnológico del Cluster de la Acuicultura de Galicia (CETGA), all from Spain.
As well have participated two associated partners from United King-
dom (UK) and France: Agri-Food and Biosciences Institute and Pole Aquimer, respectively.
Final results of the project had been revealed in a series of English, Portuguese and Spanish language webinars, taking place on the last week. For more information is possible to follow the link www.nanoculture. ciimar.up.pt.
Studies focused on aquatic ecosystems related to aquaculture in the Atlantic area, specifically targeting organisms destined for human consumption including cultured fish, mollusks, seaweed and sea urchins.
The seminars had the presence of Julie Maguire, from Indigo Rock Marine Station; Sean Kelly, from Nanotechnologies Industry Association (NIA); Begoña Espiña (INL); Alexandre Campos, from CIIMAR; Pedro Pousão-Ferreira, Director S2AQUA; Alexandre Campos y Mário Araújo, also from CIIMAR, and Garazi Rodríguez, from Asociación Empresarial de Acuicultura Española (Apromar).

The New Zealand company Mount Cook Alpine Salmon will be the first in its country to build a landbased salmon farm. The project has just been launched in Twizel (Canterbury), in the presence of the chairman of the board of directors, Bill English, and the Minister for Oceans and Fisheries, David Parker. The fish farm will cost NZD 16.7 million (about USD 9.6) to build, while the government will allocate NZD 6.7 million from the Sustainable Food and Fibre Futures fund of the Ministry of Primary Industries (MPI).
The company had reached its maximum capacity in its hydroelectric channels and needed to expand to meet demand. The goal of the new farm, which will take six years to build, is to double the company’s annual production to 6,000 to 8,000 tons of fish, David Cole, CEO of Mount Cook Alpine Salmon, told reporters. The company’s intention, moreover, is to generate no waste, returning 100% of the water used to the source.
In Cole’s words, the plan is to create a 1,000-metric-ton sustainable hybrid structure that will use a partial-flow system to emulate the unique conditions of glacier-fed channels. The facility will be designed to optimize energy use by gravity-feeding the water and integrating renewable and energy-efficient solutions.

“The demand for healthy, sustainably produced aquaculture products continues to grow, and landbased salmon farming will enable New Zealand to boost the supply of this high quality, high value product,” said MPI’s director of investment programs, Steve Penno.
According to Penno, the initiative “will build on our international reputation as a producer of high-quality aquaculture products, and develop another opportunity to create a nutrient-rich protein product that can be offered to consumers.”
The new project was officially unveiled in Twizel, the largest town in the Mackenzie District in the Canterbury region of New Zealand’s South Island, and was attended by the Minister for Oceans and Fisheries, David Parker, who took the opportunity to visit freshwater salmon farms and learn about the company’s plans to build the prototype.
Although it is not yet known exactly where the new farm will be located, which could be in either the Waitaki or Mackenzie districts, it is known that it will be dedicated to the farming of two types of fish, the company said.
“We are also planning to introduce a new species of salmon to New Zealand, which is sockeye salmon,” Cole told Radio New Zealand (RNZ). “We don’t quite know how the king salmon might behave in a land-based farm, so the idea of sockeye salmon,
which we know breeds very well, is a risk mitigation as well as an opportunity for New Zealand.”
For his part, Penno explained to Stuff.co.nz that “Mount Cook Alpine Salmon already has international experience in building land-based salmon farms within its aquaculture division and will draw on this knowledge. They will also consult with global experts to design the advanced water management system.”
Penno detailed that the project will generate new employment opportunities at Twizel. “This new approach to salmon farming could lead to significant employment and career opportunities in both aquaculture and applied technologies in a remote area of the country.”
“Demand for healthy, sustainably produced aquaculture products continues to grow, and land-based salmon farming will enable New Zealand to increase the supply of this highquality, high-value product,” Penno said, adding that the project is in line with the Government’s aquaculture strategy, which outlines a sustainable growth pathway for an additional NZD 3 billion in annual revenue.

Existing pilot and commercial facilities demonstrate that offshore aquaculture is technically feasible, and that it can improve growing conditions and farmed animal health under some conditions. Moreover, because offshore aquaculture occurs in ecological contexts that differ significantly from nearshore contexts, different kinds of ecological risks may also arise as the sector grows. Here, we present information on the ecological risks posed by offshore aquaculture and how to mitigate them.
Interest in growing fish, seaweed, and shellfish has grown markedly in recent years in recognition of the growing and potential contribution of aquaculture to marine food production, nutrition, and economic development. Siting aquaculture operations in waters, where there are fewer claims on marine space and higher water quality, may reduce constraints on marine food production systems. The space available for growing food offshore is considerably larger than is needed to meet global food demand under certain assumptions.
Certain offshore environments also offer natural subsidies, such as higher water quality, flushing, nutrient delivery, and assimilation, with some evidence that the greater depths and currents characteristic of offshore environments also improve growing conditions. The potential benefits of farming such waters are substantial, but as with all food production systems, its development will not come without some risk to ecosystems and wildlife, particularly if the industry grows sufficiently to contribute significantly to food production, nutrition, and economic development goals.
Here we present a summary of available information on ecological risks posed by offshore aquaculture. Also, knowledge gaps related to characterizing ecological impacts likely to be associated with an expanding U.S. offshore aquaculture sector to help set a national research agenda that could fill these gaps and inform the development of policies capable of facilitating industry growth while minimizing adverse environmental impacts.
As interest in offshore aquaculture has grown, several approaches to facility de-
sign have emerged. These approaches can be categorized as either open-pen design or closed containment, each with several sub-categories of design within them.
Open-pen designs are those which use only mesh-style barriers to contain the farmed population, allowing free, three-dimensional exchange between the ‘internal’ farm environment and the ‘external’ ambient environment. The most common open-pen designs are surface structures, which suspend mesh fish containment barriers from floating infrastructure, are moored to the
seafloor by a series of strategically placed anchors, and have tensioned lines to maintain the shape of the net pen as currents act upon it.

In contrast to open-pen designs, closed containment designs physically separate the ‘internal’ farm environment from the ‘external’ ambient environment. Physical separation allows isolation of the farm population from potentially harmful ambient risks like pathogens, parasites, and algae blooms, as well as the opportunity to remove or treat farm waste products. However, this eliminates natural subsidies afforded
There has been increasing interest in growing finfish, shellfish, and seaweed in U.S. offshore waters during the past decade, resulting in greater investment and development of support and research programs.
Governance and regulatory systems for offshore aquaculture remain largely under-developed, and very few countries have any regulations that explicitly mention offshore or openocean aquaculture.
by open pen designs, introducing the need to intake, circulate, and discharge water, as well as maintain its quality to support fish health and growth.
There has been increasing interest in growing finfish, shellfish, and seaweed in U.S. offshore waters during the past decade, resulting in greater investment and development of support and research programs. Governance and regulatory systems for offshore aquaculture remain largely under-developed, and very few countries have any regulations that explicitly mention offshore or open-ocean aquaculture. Offshore operations can be complicated to regulate under existing legal frameworks because of stakeholder conflict, maritime jurisdictional issues, and understudied environmental impacts.
U.S. policymakers have pursued a variety of approaches to regulate offshore aquaculture. However, while
these efforts are all aimed at increasing U.S. aquaculture production, aquaculture proponents have identified governance, siting issues, and permitting issues as the most significant obstacles to increasing U.S. operations. In addition, offshore aquaculture requires regulatory certainty and long lease periods to reduce risk for investors and justify large capital expenses associated with constructing and operating a new facility. The lack of aquaculture-specific federal policy for offshore facilities in the U.S. has driven most offshore aquaculture initiatives to operate in state waters (or in other countries) that offer similar conditions and degrees of exposure to what is expected from sites in federal waters (Table 1).

Many of the practices that have improved nearshore aquaculture outcomes over the past 20 years will likely be employed in offshore
aquaculture. However, there may be some attributes of offshore aquaculture that will generate different kinds of risks and thus require different mitigation strategies. To develop a sound policy that can facilitate the development of the offshore aquaculture industry in U.S. federal waters without compromising the health of ocean ecosystems, it will be necessary to understand the main risks that offshore aquaculture poses to marine ecosystems and wildlife; which risks can be mitigated using current approaches; and which risks will require new or precautionary approaches.
Selecting appropriate sites for offshore aquaculture presents several challenges, which together create a risk for cumulative impacts. The U.S. offshore marine environment is more crowded than it would appear to be at first glance. As a result, offshore aqua-
culture facilities have limited possible sites due to a high number of preestablished claims on space and other factors.
Knowledge Gaps:
9 What is the long-term risk that commercial offshore aquaculture operations would aggregate given the need for favorable growing and operating conditions and existing claims on marine space?
9 Are the existing regulatory tools appropriate for regulating offshore industry development, or should sector-wide development plans, underpinned by carrying capacity modeling, be used to prevent adverse cumulative impacts?
9 How can technology best be leveraged to improve siting and monitoring?
9 What are the best approaches for choosing sites for offshore farms such that production and environmental performance are optimized?
9 How will climate change affect ecological risk associated with offshore aquaculture given changes in species migration, abundance, and distribution? How can these changes be factored into planning and permitting decisions?
9 How is the U.S. offshore aquaculture industry going to be monitored effectively in remote locations?
The production and installation of infrastructure (e.g., cages, pens, moorings) capable of containing farmed species in high-energy offshore environments poses a great technical challenge. Offshore aquaculture infrastructure and equipment must withstand or be resilient to strong offshore waves, winds, and currents as well as resist corrosion and fouling. Plans to use pre-existing infrastruc-
ture like decommissioned oil rigs or marine wind farms have been considered globally, including examples such as Belgium’s Wier and Wind project and Germany’s offshore mussel and wind turbine sites. Loss of or damage to infrastructure during transport, siting, operation, and decommissioning could result in damage to vessels, lethal accidents, and the entanglement and killing of marine animals as the lost gear drifts.
9 How can the risk that aquaculture infrastructure will be lost or damaged during transport and deployment be mitigated?
9 What are risks associated with decommissioning an offshore aquaculture facility?
9 While fishing pressure could be addressed with existing management frameworks, what are the most effective strategies for mitigating other risks associated with fish and wildlife interactions with offshore aquaculture infrastructure, like disease transmission or entanglement?
With few exceptions (e.g. tuna ranching operations), stock for on-growing at offshore finfish farms is expected to come from hatchery production.
For well-established farmed species, broodstock are obtained from hatcheries which are typically sited on land. For more novel species, broodstock may be wild caught, and risks include over- exploitation of the wild population and by-catch during collection, though the relatively few individuals necessary for broodstock cohorts limits this risk.
The environmental impacts of land-based brooding and rearing systems include habitat modification for facility construction, operational energy and water consumption, and metabolic waste disposal. In U.S. hatcheries, most of the energy con-
sumed is for water circulation and feed distribution, and most of the energy is sourced as electricity or natural gas.
Knowledge Gaps:
9 What data are necessary to collect to determine optimal stocking densities for a specific species in a given locale? How should the optimum be defined?
9 What are the most efficient strategies to produce sufficient stock for each of the species being considered for offshore production and how can the constraints on their production be overcome?
9 How can the carbon footprint of hatcheries and pre-stocking rearing operations for offshore farms be further reduced?
Feed is a critical driver for the economic and environmental footprint of aquaculture; for example, feed generally represents 50–80% of production costs of fed aquaculture and is typically the most significant contributor to fed aquaculture’s greenhouse gas emissions. Additional environmental concerns with feed include overall efficiency of converting feed to aquatic animal growth, the sustainability of feed ingredient resources, and the effects of feed lost to the environment. Feed production and use for aquaculture occurs within a broader food systems context, necessitating the consideration of a wide range of environmental impacts, including to terrestrial and freshwater habitats.
Knowledge Gaps:
9 What are the most feasible ways to continue to incentivize the efficient use of fishmeal and fish oil content in aquaculture feeds?
9 How can robust and consistent understanding of the ecological and social implications of feed use and manufacturing be achieved?
Offshore aquaculture infrastructure and equipment must withstand or be resilient to strong offshore waves, winds, and currents as well as resist corrosion and fouling.
9 What are the key performance indicators and targets for fed aqua- culture (e.g., FCR, FFDR, GHG emissions) to be considered for sufficiently responsible offshore production in the U.S.?
9 How do the respective environmental consequences of current and future feed ingredients compare and what are their limitations?
9 How can technological, policy, and market developments accelerate the process of improving feed conversion ratios and feed formulations?
9 What are the next steps in the industry for using technology to reduce feed loss, and how can feeding efficiency be further improved?
While diseases and parasites are initially transmitted from wild to farmed fish, their amplifica -
tion in aquaculture conditions is of concern. For offshore farms, the increased physical distance of facilities from the shore reduces interaction with coastal flora and fauna and minimizes the risk of disease and parasite infections. Environmental modeling and spatial planning can be used to assess hydrodynamic connectivity and minimize disease transmission. Concerns about disease outbreak due to cumulative impacts of multiple farms in the same area can be mitigated with the management of spatial distribution of farms.
Knowledge Gaps:
9 What are the population level impacts of offshore escapes on marine ecosystems?
9 How can existing monitoring systems, used to detect outbreaks of disease, parasites, and fish escapes, be further improved and coupled with
protocols to minimize potential risks to wild species and ecosystems?
9 What siting criteria would minimize the risk of disease and pathogen outbreaks within farms, as well as minimize spread to local wildlife?
9 Will certain types of offshore aquaculture infrastructure pose fewer risks of escapes than others?

9 Is the use of cleaner fish likely in offshore aquaculture, and if so, would this practice pose ecological risks due to escapes and can it address concerns around cleaner fish welfare and overharvesting?
9 How can the prevalence and distribution of pathogens in wild populations be better characterized to better understand disease trans- mission to farmed animals and vice versa?
Although offshore aquaculture is a nascent industry globally, many pilots and several commercial operations have demonstrated that it is technically and perhaps economically feasible, and many lessons can be learned from them.

Many of the ecological risks associated with offshore aquaculture can probably be mitigated using wellestablished methods. The risk of cumulative impacts arising from the need to satisfy several siting criteria simultaneously can be managed with planning processes and cumulative risk modeling and analysis. Stocking can be optimized through continued research on how to take advantage of higher currents and other conditions that can improve growth conditions and reduce the need for high stocking densities. Feed impacts can be mitigated by advances in the development of low-carbon and cost-effective alternatives to fishmeal/fish oil and
continued improvement in food conversion ratios, as well as through the continued development of precision feed delivery systems that minimize feed loss.
Offshore aquaculture in the United States has strong potential for positive impacts, such as benefiting local seafood production and economic development. U.S. aquaculture facilities operating within a strong and well enforced regulatory system could potentially produce seafood with relatively fewer environmental impacts compared to seafood grown and harvested in contexts with weaker regulation, or in areas that are farther from major markets. More research will be required to fill remaining knowledge gaps related to the characterization and mitigation of ecological risks associated with offshore aquaculture, both to develop best practices and performance standards, and to develop policies that ensure the adoption of these practices and standards.
This is a summarized version developed by the editorial team of Aquaculture Magazine based on the review article titled “TOWARD AN ENVIRONMENTALLY RESPONSIBLE OFFSHORE AQUACULTURE INDUSTRY IN THE UNITED STATES: ECOLOGICAL RISKS, REMEDIES, AND KNOWLEDGE GAPS” developed by: ROD FUJITA - Environmental Defense Fund; POPPY BRITTINGHAM - Stanford University; B, LING CAO - Shanghai Jiao Tong University; HALLEY FROEHLICH - University of California; MATT THOMPSON - New England Aquarium; TAYLOR VOORHEES - Monterey Bay Aquarium and Cargill, Inc. The original article, including tables and figures, was published on OCTOBER, 2022, through MARINE POLICY. The full version can be accessed online through this link: https://doi.org/10.1016/j. marpol.2022.105351
Offshore aquaculture in the United States has strong potential for positive impacts, such as benefiting local seafood production and economic development.
In the 1990s, a US market for European sea bass was almost nonexistent. Since the turn of the century, imports have grown from zero to almost 10,000 metric tons. From 2015 when the quantities became more significant, the species entered the large whitefish market, although with a significant price premium relative to tilapia, the largest species in this market. This increase in imports suggests strong seafood demand, which in general creates good conditions for aquaculture production to grow.
 By: Aquaculture Magazine Editorial Team*
By: Aquaculture Magazine Editorial Team*
The U.S. is the world’s largest seafood importer by value, and imports are rapidly increasing. Even though the U.S. is the world’s sixth-largest fishing nation, imports dominate the market as imports are estimated to make up between 65% and 90% of total U.S. seafood consumption. U.S. fisheries landings have been relatively stable for decades, and as most stocks are well managed but fully exploited there is little opportunity for increased supply from this sector. This is particularly true for fresh fish, as limited quantities of domestic wild-caught fish are marketed fresh. The increase in imports suggests strong seafood demand, which in general creates good conditions for aquaculture production to grow. Globally, the aquaculture sector has grown rapidly as the landings of wild fish have stagnated. However, this has not impacted the U.S. aquaculture sector very much, indicating that the opportunity created by increased seafood demand is not being exploited by US aquaculture producers. In this article, we present a paper that use the developments in
the imports of one niche species, European sea bass (Dicentrarchus labrax), which is marketed as Branzino in the US, to show that the market is not one of these constraints.
Sea bass aquaculture in the Mediterranean European sea bass is the most important farmed fish in the Mediterranean region. Sea bass is grown in marine sea-pens, and reaches a market size of 300–500 g in 15–18 months. According to the FAO (2021), farmed sea bass production reached 263,215 mt in 2019. Turkey is the main producer with 52% of the production, followed by the EU with 32% and Egypt with 12% (Figure 1). The share of Turkish production of sea bass has been rapidly increasing since the early 2000s, as Turkish sea bass production has been increasing much faster. In the EU, the main farmed sea bass producers are Greece (16% of the total sea bass production), followed by Spain (10%) and Croatia (2%). Wild sea bass catches are minor, accounting for 5,206 mt in 2019.
Total sea bass production has grown, at an annual rate of 7.6% but this varies considerably by country, with the highest annual growth rate of 12.5% in Turkey and a much lower growth rate of 4.0% in the EU. Aquaculture production in the EU has increased slightly, despite significant investment aimed to boost aquaculture production. Lower growth in the EU aquaculture sector can be mainly explained by heavy regulatory burden in terms of both time and impact assessments required, difficulties in access to space and water with competing sectors contributing to higher costs, together with keen market competition as increased imports from Turkey put downward pressure on prices. The sea bass aquaculture in Turkey has lower production cost and is more profitable than in the EU.
The U.S. market for sea bass
European sea bass is commonly marketed by U.S. chefs under its Italian
name, Branzino. It is a fish with white, flaky meat and a mild, sweet flavor, and it is popular on menus of upscale restaurants in the Northeast U.S. and Southern California. In the 1990s, a U.S. market for European sea bass was almost nonexistent, with as little as 37 mt imported annually (Figure 2) and virtually all of this was frozen. As aquaculture of sea bass gained momentum in the Mediterranean and producers there faced increasing competition and lower prices, they started looking for new markets. The U.S. became one of these as imports of sea bass slowly increased in the 2000s.
In the U.S. import data, sea bass is not separately identified until 2012.

However, there are limited imports of any other species from Greece, Italy, and Spain. Hence, it is reasonable to assume that fresh imports of sea bass from Greece, Italy, and Spain are classified as non specified marine fish prior to 2012 in the U.S. trade data. As shown in Figure 2, this provides an almost seamless transition between 2011 and 2012. It was not until the early 2010s that fresh sea bass markets in the U.S. became better established, as illustrated by the rapid increase in fresh imports (Figure 2). Imports of sea bass increased more than threefold from 2,977 mt in 2012 to 9,650 mt in 2019. Nearly 90% of sea bass imports were whole fresh, gutted fish

at so-called portion size (1lb to 1.5 lb). Using a live weight conversion factor of 1.12, this is equivalent to 10,005 mt live weight of fresh sea bass. This is significant, as it is comparable to U.S. farmed Atlantic salmon production (16,107 mt) and about half of U.S. rainbow trout production (22,370 mt). Similarly, fresh imports of sea bass were valued in 2019 at $52.4 million, which is slightly less than the value of U.S. farmed salmon production ($67.3 million) and more than half of the value of U.S. farmed rainbow trout ($95.7 million). This is a quantity and value that would make sea bass the fourth-largest farmed finfish species by value if it had been produced domestically in the U.S.
The trends in U.S. imports of sea bass largely reflect where the production takes place as well as market competition. The increase in exports to the U.S. was led by Greece, whose producers faced increasingly keen competition from Turkish producers targeting the EU market. In 2004, Turkey overtook Greece as the largest producer of sea bass. As Turkey’s total production has increased, Turkey has steadily taken market share from Greece, including in the U.S., and in 2018 Turkey became the largest supplier of sea bass in the US market. The rapid development of the U.S. sea bass market is indicative of the strong demand for fresh fish in the U.S. Moreover, being sold as portionsized fish is a clear indication that the market is open to nonstandard product forms as long as the product is competitive on price and quality.
Many authors have noted how aquaculture producers increase their competitiveness in the supply chain by being able to supply products of stable quality with a high degree of reliability. Figure 3 shows the average import volume of sea bass per month to the U.S. for the period 2012 to 2019. The figure shows a steady supply of fresh products with virtually no seasonal variation. Hence, it is the market and not the natural pro-
duction cycle that is determining the supply profile, and the exporters can deliver the same volume year-round. This is often a challenge for aquaculture producers in the U.S., where the harvest is dependent on the growth cycle. The parallel to fisheries with a race to fish is obvious.
Garlock, Nguyen, et al. (2020) discuss in the case of U.S. aquaculture production how potential production faces three competitive scenarios: it can create new market segments, it can win market share from domestic wild fish, and it can win market share from imports. A potential importer faces similar scenarios. Figure 4 shows the price development for sea
bass together with the price development for tilapia, the most consumed farmed whitefish species in the U.S. market. Two features are apparent. There is a sharp decline in unit price of imported sea bass between 2012 and 2019. The average unit price in 2012 was $10.00 per kg, which fell to $5.90 per kg in 2019. This is steeper than the price decline in Europe, suggesting that exchange rates have been beneficial in addition to productivity growth for the competitiveness of sea bass in the U.S. The declining trend in the sea bass price follows a very similar pattern as the price of fresh imported tilapia fillets from 2015, indicative of market integration. How-


ever, while the price of sea bass averaged $5.90 per kg in 2019, which is similar to the average price of $6.02 per kg for tilapia fillets, this implies a significantly higher price for round sea bass as it is head-on fish.
In recent decades, increased trade has made the seafood market global for most species, as seafood has become the most highly traded food category. Several studies investigating market integration for specific species or groups of species report that there is a global market for most species groups, but that the markets for different species groups are not integrated. In a global market, the price development over time is similar in all regions, even though there may be differences in price levels because of transportation costs and quality differences, as a shortage in one region is corrected by increases in imports from other regions. However, there are exceptions in the case of wild relative to farmed fish for some species. Factors that may prevent market integration include high transportation costs leading to a lack of trade, or differences in product characteristics.
The main tool used in the literature to investigate the degree of market integration is to investigate the relationship between the prices of different markets. The results of market integration tests are reported in Table 1 using data starting in January 2015. The results indicate that one cannot reject the null hypothesis of one cointegration vector. Moreover, as one cannot reject the law of one price hypothesis, the two species share the same price determination process from 2015. Hence, a successful new aquaculture product does not seem to be able to maintain a separate niche for very long but seems to be rapidly driven into an established market segment, where the best it can do is to obtain a premium associated with quality or other characteristics that consumers prefer. However, the premium can be significant. This is potentially of great importance for U.S. aquaculture producers.
The tendency demonstrated in several studies for U.S. consumers to prefer domestically produced fish to imports, and with a limited preference for wild fish, is important if domestically farmed seafood is to be competitive and maintain a price premium relative to imports.
Sea bass is a recent addition to the U.S. seafood market, and the species appears to have been well received given the rapid increase in imports. This strongly suggests that there is still room for new species in the market, and it is not too hard to introduce them if the price and quality point is reasonable. Hence, demand does not appear to be a significant constraint for potential U.S. aquaculture producers. Moreover, it strongly suggests that it is possible to develop niches for new species and product forms even in a market that is dominated by a few, mostly imported, species. However, at a relatively moderate quantity, imported sea bass started to compete in the larger whitefish market where tilapia is the leading species, although obtaining a premium. This shows that there is relatively little room to develop new independent market segments, as most products in the U.S. get pulled into one of the large species groups for which there are global markets. For an expanding industry this may be an advantage, though, as the price effect is limited by the larger quantity in the market that one enters.
The result that foreign aquaculture producers of a new species can create a new market segment in the U.S. with relative ease suggests that this is also an avenue that is open to U.S. aquaculture producers. One
company in Connecticut has started U.S. production of sea bass in re- circulating aquaculture systems, which are arguably more environmentally friendly than the sea-cage farming used to produce imported sea bass, but production is minor. That U.S. producers are not able to exploit this opportunity is a strong indication that their main challenges are to be found in other places in the supply chain. Knapp and Rubino (2016) strongly suggest that the regulatory system is the main culprit, and this is substantiated in recent work (Van Senten et al. 2020). However, this does not appear to be an easy issue to solve, and Guillen et al. (2019) show how the EU struggles with similar challenges in relation to its aquaculture industry and similarly ends up with increasing demand being served by imports. Hence, while increased aquaculture production is an economic opportunity, as observed by Garlock, Asche, et al. (2020), it is an opportunity that developed countries fail to exploit despite struggling coastal communities and increasing demand for sustainably produced protein.
This is a summarized version developed by the editorial team of Aquaculture Magazine
on the review article titled “MARKET OPPORTUNITIES FOR US AQUACULTURE PRODUCERS: THE CASE OF BRANZINO)” developed by: FRANK ASCHE - University of Florida and University of Stavanger; TARYN GARLOCK and EDWARD CAMP - University of Florida; JORDI GUILLEN - European Commission Joint Research Centre; GANESH KUMARMississippi State University; IGNACIO LLORENTE - University of Cantabria; GINA SHAMSHAK - Goucher College. The original article, including tables and figures, was published on MARCH 2022, through MARINE RESOURCE ECONOMICS. The full version can be accessed online through this link: https://doi.org/10.1086/718437

The historic castles, churches and pastel-coloured port towns lining the shores of the small volcanic island of Procida in the Bay of Naples have earned it the award of the 2022 Italian Capital of Culture. It is the rich and dynamic marine ecosystem hiding underwater off the island’s coasts, however, that has made it the site of a unique and innovative effort in a different kind of culture: aquaculture.
The historic castles, churches and pastel-colored port towns lining the shores of the small volcanic island of Procida in the Bay of Naples have earned it the award of the 2022 Ital-

ian Capital of Culture. It is the rich and dynamic marine ecosystem hiding underwater off the island’s coasts, however, that has made it the site of a unique and innovative effort in a different kind of culture: aquaculture.
It is this developing sector that drew the General Fisheries Commission for the Mediterranean (GFCM) aquaculture team to Procida in July. There they completed a field visit on sea urchin aquaculture to collect mate-
rials and conduct underwater research in order to launch a pilot action on sea urchin restocking.
“Sea urchin farming is a new activity that combines innovation with the restoration of ecosystems. As such, it must be well studied and thought out so that models can be proposed for the Mediterranean region” said Houssam Hamza, GFCM Aquaculture Officer.
The purple sea urchin (Paracentrotus lividus) is considered to be one of the most important herbivores in the Mediterranean Sea and is a famous culinary delicacy in many countries. As one of the organisms defining the ecological system in the region, P. lividus has long been used as an animal model in developmental biology and as an indicator in the assessment of environmental quality.
“This species is very important for ecosystems, because it transfers energy from primary production, i.e. from plants, to other ecosystems, and it is also fundamental for scientific research, as it has a very special embryo that makes it possible to carry out research on evolution and development” said Valerio Zupo, Senior Scientist at
Stazione Zoologica Anton Dohrn, Naples.
Contrary to what their robust appearance may suggest, sea urchins are very sensitive to environmental conditions, especially in the early stages of life, and they require intensive monitoring and special attention during the production process. The overall status of the sea urchin populations in the Mediterranean is of concern. As a precaution pending formal stock assessments, sea urchins should be considered in need of conservation due to the impacts of fisheries and climate change, among other factors. Nevertheless, their numbers, spread and impacts are different around the region depending on local conditions and harvesting.
Given the importance of the species as a resource for fisheries and the determinant role it plays as a macroherbivore, regulating the volume of algae and helping to maintain balance in the ecosystem, the GFCM’s pilot action aims to support effective and innovative restorative aquaculture practices as a solution to revive the sea urchin’s populations.
Sea urchin farming is a new activity that combines innovation with the restoration of ecosystems
Within this pilot project, the GFCM is working to support and advise aquaculture enterprises that are involved in the production and restocking of sea urchins in the Mediterranean and Black Sea region. One such enterprise is Echinoidea, a small-scale aquaculture facility in Procida, which was established in 2016 by Michele Trapanese, who manages the farm with his two children, Chiara and Filippo. Echinoidea is combining business with conservation to achieve trailblazing advances in the production of farmed sea urchins, which are valued for their delicious roe, and in the restocking of sea urchin populations in the area.

This species is very important for ecosystems, because it transfers energy from primary production, i.e. from plants, to other ecosystems
of Naples, female and male gametes are extracted from individuals selected for in vitro fertilization in the laboratory, and the juveniles obtained are placed under continuous surveillance and controlled rearing conditions (temperature, water quality and feeding) over the course of the entire production cycle, which usually lasts about nine months. Once the adults are ready, they are released back into their natural environment to continue growing in an area specifically intended for aquaculture.
The GFCM’s pilot action aims to support effective and innovative restorative aquaculture practices as a solution to revive the sea urchin’s populations

“As a young woman, it is important and meaningful for me to participate in this project which is all about environmental protection, sustainable fishing and green economy” said Chiara Trapanese, Administrator at Echinoidea.
The farm produces urchins in a closed recirculating aquaculture system (RAS) and was successful in leading preliminary experiments of artificial fertilization and rearing of sea urchins in collaboration with the research institute Stazione Zoologica Anton Dohrn. Following the collection of mature urchins in the Gulf
Although the Procida pilot project still requires further development and coordination with stakeholders, it has the potential to become a model case study for echinoculture that could be expanded across the Mediterranean Sea.
“In Procida, we are experimenting with new forms of aquaculture. Sea urchin breeding is certainly an innovative activity that fits into the strong mussel farming tradition of our region,” said Nicola Caputo, Counselor for Agriculture at the regional government of Campania.
In this regard, the GFCM organized a seminar on 4 October 2022 in Procida in collaboration with the
Centre for services, assistance, studies and training for the modernization of public administration Formez PA, the Italian Ministry of Agriculture, Food and Forestry Policies and the regional government of Campania.
The seminar titled “Sea urchin and seaweed production and management: stateof-the-art and experiences in the Mediterranean” included among the participants local authorities, representatives of administrations and small-scale fisheries, fish farmers and researchers. It aims to be a moment of collective discussion on the challenges and opportunities that these sustainable aquaculture activities can represent for the sector, the protection of the sea and the environment, diversification in fish food production, and the possibility of bringing additional benefits to local communities.
The GFCM will continue supporting this and other initiatives in the region to promote restorative aquaculture.
United Nations (FAO) Palazzo Blumenstihl – Via Vittoria Colonna 1, 00193 Rome, Italy
Tel: +39 06 570 56566
URL: www.fao.org/gfcm

If ever durable products were required, it is probably most visible in the fishing and aquaculture industries. Your underwater cages and mooring systems need shackles, bolts and other mooring accessories that are below surface, but above standard. That is why the Green Pin® aquaculture products are the top choice for fish farmers.
If ever durable products were required, it is probably most visible in the fishing and aquaculture industries. Equipment is constantly exposed to water, salt and different temperatures. For aquaculture, cages need to be secured under water reliably for longer periods of time to safeguard large investments. Your underwater cages and mooring systems therefore need shackles, bolts and other mooring accessories that are below surface, but above standard. That is why the Green Pin® aquaculture products are the top choice for fish farmers.
What’s more, the products within the new Green Pin® aquaculture
range have been designed, extensively fatigue-tested and DNV type approved by the NS 9415 standard as required by NYTEK regulation. Galvanization of Green Pin® lifting accessories assures long-term durability, even under harsh, salty conditions. The products in our range to safeguard your investments are:
The Green Pin® Mooring Bow Shackle NS9415 BN is a bow shackle with a safety bolt and a sunken bolt head that has been designed for mooring applications. The shackle offers a double safety (safety bolt and synthetic cotter pin) which prevents

accidental unscrewing of the pin. The sunken bolt prevents rotation of the bolt, making it much easier to assemble. It also minimizes the risk of damage to the cage net or mooring line. The wider shackle mouth enables you to connect the shackle to a mooring or connecting plate which is wider than usual.
The Green Pin® Dee Shackle
Safeguard your aquaculture investment with the strongest and most durable aquaculture shackle on the market. The new Green Pin® screw pin shackle features a double safety (bolt and plug). With an industryleading safety factor of 7 x WLL and
a fatigue-rating of over 40,000 cycles (twice the minimum requirement).
The Green Pin® Dee Shackle NS9415 FP is an exemplary shackle in this product line. Its square, sunken hole screw pin combined with a safety plug makes it a double safety product that is easy to assemble and disassemble with the Green Pin® Sunken Hole Key.
The Green Pin® Bow Shackle BN is a bow shackle with a safety bolt. The shackle offers a double safety (split pin and safety bolt) which prevents accidental unscrewing of the pin. The Green Pin® Bow Shackle NS9415 BN is suitable for both one-leg and multi-leg systems.

The Green Pin® Mooring Bolt NS9415 T for mooring underwater cages to the seabed, aimed at the burgeoning aquaculture market. This product excels in the safety and security it provides.

This mooring bolt is a grade 8 mooring bolt with a T-shaped end fitting that provides best-in-class quality, guaranteeing absolute security for your mooring system. The mounting depth is indicated by the green color, which makes the installation of the product much easier and the special type of thread will result in a better fixation of the bolt.

The Green Pin® Master Link NS9415 GR8, is a grade 8 master link. The Master Link is certified according to DNV NS 9415 and has a large opening to accommodate larger connecting links. This master link is designed for a one- or two-leg sling.
Green Pin® creates high-end lashing and lifting equipment such as shackles, turnbuckles, hooks and fiber link chain. The raw materials come from high quality suppliers who guarantee full traceability, and the automated production facilities greatly reduce margins of error. Green Pin® products comply with a wide range of internationally recognized standards and are certified by class societies such as DNV. Combined with product quality, Green Pin® offers unrivalled product availability that is fast, global and extremely reliable. The company has an industry-leading stock availability of 99% and is available in more than 90 countries across the globe. Green Pin® products are also accompanied by CAD-drawings, technical documentation, a technical helpdesk, and a suite of technical trainings.
For more information, please visit http://www.greenpin.com.
The EU aquaculture industry is a politically prioritized industry as shown in the EU’s Farm to Fork Strategy. However, while a lot of attention has been paid to the economic importance and environmental impact from the aquaculture sector, there has been less focus on the social dimension. This article presents a review of the employment in the sector presenting demographic information on gender, age, education and nationality.
By: Aquaculture Magazine Editorial Team*The European Union (EU) aquaculture sector provides jobs for 69,000 persons in 15,000 enterprises. This includes ten thousand owners and family members engaged in small family driven businesses contributing to the social dimension.

Employment is an important part of the social dimension of aquaculture sustainability, and the EU has strongly committed to the UN Sustainable Development Goals (SDGs) where social objectives are important. This is captured in the strategic work of the EU as shown e.g. in the European Green Deal (European Commission, 2019).
In this paper, social indicators for the aquaculture industry in the EU are presented for the first time. This provides a first overview of the social status of the marine industries within the EU and its Member States and can be used to identify important clusters that are employed within the industry.
Employment is an important part of the social dimension of aquaculture sustainability, and the EU has strongly committed to the UN Sustainable Development Goals (SDGs) where social objectives are important.

The demographic data cover information about numbers of persons employed by gender, age, education level and nationality. Data collected for the analysis cover 18 countries –Bulgaria, Croatia, Germany, Greece, United Kingdom, Denmark, Finland, France, Ireland, Italy, Latvia, Malta, Netherlands, Portugal, Romania, Slovenia, Spain and Sweden.
Results by member state Gender. In Figure 1 the overall gender distribution of the employed in the EU aquaculture sector is shown.
The sector is dominated by male employees covering 77%, while female employees cover 22% of the workforce. The gender distribution is shown for each country. The percentage of female employees in the different countries ranged between 0% in the Netherlands and up to 38% in Germany. The Netherlands has a relatively small sector, which consists of highly advanced recirculation facilities, whereas the German sector covers sea based blue mussel farming and land based traditionally earth pond trout and carp farming. Equally interesting is the
social dynamics of the presence of cooperatives of women who raise bivalves (mainly mussels), a dynamic that characterizes the employed in central-northern Adriatic Regions.
Age. In Figure 2, the age class structure for the overall EU aquaculture sector is shown. The age class 40–64 covers the most years and is also the largest in terms of employees, covering 45% of the people employed. The second largest group is the age class 25–39 covering 28%. The employees are distributed by age for each country. The percent -
age of the age group 40–64 was highest in Slovenia (81%), Bulgaria (68%) and Finland (67%), whereas the age class 25–39 dominated the employment in Malta (51%), followed by Croatia (40%), and the UK (39%). The highest percentage of employees over 65 years is found in Romania with 32%, followed by Portugal and Sweden covering 16% and 11%, respectively.
Education. In Figure 3, the education level for the EU is shown. Overall, 39% of the persons employed in the aquaculture sector reported a low level of education, followed by 35% with a medium level education. For 9% a higher-level education was reported, whereas 17% was reported as unknown. The countries showing the largest percentage within the group of highlevel education were Latvia (35%), Germany (26%), Romania (23%) and Sweden (23%). In contrast, Italy (73%), Spain (58%) and Portugal (47%) had the most people with a low-level education employed in the aquaculture sector.
Nationality. Figure 4 shows that the majority of the employees, making up 85%, were nationals of the country where the production took place. 2% originated from other EU countries and 3% were employees from non- EU/EEA countries. Also, it can be seen that in all the countries surveyed, nationals are the dominant source of employment.

Gender. The gender distribution is approximately equal for all sectors with about 20–25% female employees. The male dominance is consistent for all production technologies and sectors although differences occur. The technology with the highest share of females is the shellfish production technology on bottom having a share of 30% females. The

on bottom shellfish technology is the largest in terms of employees with approximately 21,000 employed persons where the majority (58%) are employed in France.
Age. The age category 40–64 years covers the largest interval (25 years) and is the category covering the largest share of the employees in the production sectors and for most production technologies as well.
The sector is dominated by male employees covering 77%, while female employees cover 22% of the workforce.
Overall, 39% of the persons employed in the aquaculture sector reported a low level of education, followed by 35% with a medium level education.
The sectors show rather equal age distributions with a slightly younger workforce in the shellfish sector. 9% of the employees in the shellfish sector are below 25 years and 28% are between 25 and 39 years of age. Notably, the freshwater segment has the highest share of employees over 65 years (11%). The technology with the highest share of young employees (15–39 years) are enclosures and pens followed by others.
Education level. From all the demographic variables collected for the EU aquaculture sector, education level is the one showing the highest fluctuations when looking at sectors and production technologies. Employees with a low educational level dominate both the marine and shellfish sectors, while freshwater production is dominated by employees with a medium level education (50%).


Nationality. Persons from their respective home nations dominate employment in all sectors and within all production technologies. Most technologies employ a small percentage from outside the country. An exception is the longline technology where 13% is from the EEA countries and cages where 16% is from non-EU/EEA countries. The reason cages have a relatively large share of non-EU/EEA country employees is that a large part of the seabass and seabream industry is located in Greece and the tuna farming in Malta, which are also the countries with the highest share of non-EU/EEA country employees.
A structured collection on demographic indicators is an important tool for the EU to be able to plan, execute and evaluate the EU strategies towards SDG goals and further social development in the EU. The EU aquaculture industry is heterogeneous, containing multiple species and production technologies. With many of these having different social settings, EU policies for developing the aquaculture sector
The on bottom shellfish technology is the largest in terms of employees with approximately 21,000 employed persons where the majority (58%) are employed in France.

might face different obstacles or have different impacts on society depending on which specific species or technology that is targeted. For example, production of freshwater species in ponds has a low level of young employees indicating that policies aiming for increased production need to target issues with recruitment. Similar issues could be expected for aquaculture in ponds, but not for some of the other production technologies. For example, in the Longline mussel production, close to 40%t of the staff is below 40 years, indicating a considerably younger workforce. The employees working with this technology are, on the other hand, poorly educated with almost 50% having a low education.
Thus, expanding aquaculture production using Longline technology is expected to provide employ-
ment opportunities for younger and less educated citizens compared to production in freshwater ponds. The examples above provide insights about how the social data can be used for targeting specific objectives within EU aquaculture policies including support to the sector through the European Marine, Fisheries, and Aquaculture Fund. By taking into consideration age, education, gender, etc. for different production technologies it is possible to overcome obstacles or take social considerations into account.
Considering the technical development within the EU aquaculture sector, more and more attention and effort has been put into the development of high performance production systems. These systems aim at producing high volumes with the lowest possible environmental impact generated, most often rep-
resented by larger scale closed or semi closed fresh water production systems (Nielsen et al., 2016). The reason for this is that economies of scale exist in the aquaculture sector (Nielsen, 2011) and that aquaculture is competing with agriculture when it comes to emission of nutrients, such as, nitrogen and phosphorus.
For the shellfish sector the situation is quite different as shellfish do not require feed and are extracting nutrients from the marine environment. This type of aquaculture is performed close to the coastline, it is quite labor intensive and does not require highly skilled labor. An increased shellfish production is therefore more dependent on access to labor, space for production and avoiding disease. Investments in training of employees may help obtain greater professionalization
that could help boost blue growth in aquaculture.
The importance of social indicators is not only a political topic but has also proven interesting from a biological standpoint, especially within fisheries- and ecosystem based management where the development of management strategies might be supported/opposed by local fishing communities depending on social factors (Waldo et al., 2020). The report WGSOCIAL (a specific working group on social indicators) identified a list of important concepts to measure, such as well-being, livelihood, capabilities, knowledge, place, social dynamics, demographic and geographic characteristics, fairness, engagement, governance, etc. (ICES, 2021). These metrics might be used for a comprehensive social evaluation of
the seafood sector as a whole. The collection of demographic variables for fisheries, processing and now also aquaculture are important steps towards social science in the sector.
A more comprehensive collection of social data for the EU aquaculture sector covering all Member States would increase the insight that could be extracted from the data, especially concerning the freshwater sector where some countries did not report. Furthermore, the reporting of “unknown” should be reduced to increase the validity of the analysis. An increasing focus and further collection and analysis of socio- demographic data could be used for strengthening the foundation for EU policies towards reaching SDG goals, such as gender equality and quality of education, in the future.
This is a summarized version developed by the editorial team of Aquaculture Magazine based on the review article titled “COLLECTING DEMOGRAPHIC DATA FOR THE EU AQUACULTURE SECTOR: WHAT CAN WE LEARN?)” developed by: SIMONA NICHEVA- Executive Agency for Fisheries and Aquaculture, Bulgaria; STAFFAN WALDO - Swedish University of Agricultural Sciences; RASMUS NIELSEN - University of Copenhagen; TOBIAS LASNER - Institute of Sea Fisheries, Bremerhaven; JORDI GUILLEN - European Commission, Joint Research Centre; EMMET JACKSON - Ireland’s Seafood Development Agency; ARINA MOTOVA - Seafish, Edinburgh; MARIA COZZOLINO - Fisheries and Aquaculture Economic Research, Italy; AVDELAS LAMPRAKIS - Ministry of Environment and Energy, Athens; KOLYO ZHELEV - Executive Agency for Fisheries and Aquaculture, Bulgaria. The original article was published on MAYO, 2022, through AQUACULTURE. The full version, including tables and figures, can be accessed online through this link: https://doi.org/10.1016/j.aquaculture.2022.738382.

Currently electrocoagulation (EC) filtration technology is successfully applied in water purification and industrial wastewater treatment. The objective of the present study was to investigate the effects of EC in wastewater from aquaculture by providing technical means and data support for enhancing the filtration pretreatment capacity of a recirculating aquaculture system (RAS) since its application is scarce.
By: Aquaculture Magazine Editorial Team*As an environmentally friendly and healthy aquaculture technique, recirculating aquaculture has attracted increasing attention, and the continuous improvement and development of recirculating aquaculture system (RAS) procedures are now established practices. Generally, in the RAS, the effluent of the aquaculture tank is initially channeled through solid–liquid separation equipment to remove the
majority of suspended particulate matter, and subsequently through equipment that provides biological oxidation, oxygenation, disinfection and other processes, in order to achieve recycling. The pretreatment of aquaculture wastewater by solid– liquid separation equipment greatly reduces the processing load sustained by subsequent water treatment units and it reduces the overall energy consumption of the system. Nevertheless, because of the need to
ensure the smooth circulation of water in RASs and because of process and cost limitations, it is difficult to improve the physical filtration efficiency by reducing the filter pore size continuously, thus hampering the pursuit of higher filtration levels of RASs.
Electrocoagulation (EC) is also a common method for enhancing solid–liquid separation of sewage, in which the sacrificial anode releases metal cations with flocculation char-

In production, RAS uses ozone and ultraviolet synergistic sterilization to control pathogenic bacteria, which usually requires massive energy consumption.
acteristics under the action of an external electric field, then forms flocculants to absorb pollutants in the water. Through the flocculation initiated by EC processes, the small suspended particles in the wastewater coagulate into larger particles, improving filtration accuracy without changing the original filtration equipment and showing that EC–filtration technology has a great potential and application for sewage treatment procedures. However, the application of EC technology in aquaculture wastewater is rare, and the application of EC–filtration technology in aquaculture has not been reported. The main objective of the present research was to investigate the pretreatment effect of EC–filtration technology on aquaculture waste- water, which is expected to provide some reference for the future improvement of the filtration capacity of the RAS.
In the experiment, a continuous flow EC–filtration system with a laboratory scale was designed, consisting of three sections: an EC reactor, a mixed flocculator and filtration equipment. The effective volume of the EC reactor was 5 L, in which nine groups of electrodes were arranged in parallel: four groups of an-
odes were composed of Al plate or Fe plate electrodes, and five groups of cathodes contained titanium (Ti) plate electrodes.
The mixed flocculator was arranged vertically and its effective volume was about 1.5 L. It was located between the EC reactor and the filtration equipment, adapted to an upward flow design. The function of the mixed flocculator was to improve the contact frequency
between the flocculants and the suspended particles, thereby improving the efficiency of flocculation and adsorption. After the flocculation treatment by EC, the aquaculture wastewater was finally filtered. The filtration equipment used was a micro- screen drum filter whose filter pore size is generally between 50 μm and 75 μm. The schematic diagram of the EC–filtration system is shown in Figure 1.


Charged ions generated by electrocoagulation (EC) can neutralize the surface charge of pathogenic bacteria, reduce electrostatic repulsion and form flocs. In addition, the flocculants produced by EC can actively absorb and flocculate the bacteria. These flocculates are eventually removed by physical filtration.
The wastewater used in the experiment originated from effluents of the aquaculture pond used for the Litopenaeus vannamei RAS. In this experiment, five different anode combinations, three different EC reactor hydraulic retention times (HRTs) and four filtration pore diameters were used. A control group was set up without EC treatment and only relying on filtration equipment. The experiment was aimed at measuring the removal effect on the total number of Vibrio , chemical oxygen demand (CODMn), total ammonia nitrogen (TAN), nitrite nitrogen (NO-2-N), nitrate nitrogen (NO-3-N) and total nitrogen (TN) in aquaculture wastewater through the use of an EC–filtration system with different combinations of anodes, different HRTs and variable size of filtration pores. Finally, the aquaculture wastewater post-EC treatment was filtered through filtration equipment in order to complete the pretreatment procedure.
The removal effect of the EC–filtration system on the total number of Vibrio In production, RAS uses ozone and ultraviolet synergistic sterilization to control pathogenic bacteria, which usually requires massive energy consumption. Charged ions generated by EC can neutralize the surface charge of pathogenic bacteria, reduce electrostatic repulsion and form flocs. In addition, the flocculants produced by EC can actively absorb and flocculate the bacteria. These flocculates are eventually removed by physical filtration.
Figure 2(a) shows the effect of different composite anodes and HRTs on the removal of Vibrio in the EC reactor. When the HRT increased, the removal efficiency increased. It follows that the EC reactor had a significant removal effect on the total number of Vibrio . Also, without a solid–liquid separation, the removal efficiency increased with the addition of the iron elec-
trode proportion in the combined anode and with the increase of HRT. Furthermore, the experiment proved that the sterilization of Fe as anode during EC was more effective than that of Al anode, which is consistent with results reported. Figure 2(b1)–2(b3) show the effects of different composite anodes and filter pore sizes on the Vibrio removal by EC–filtration. Compared to the control group, the removal efficiency of experimental groups for Vibrio was obviously greater.
In the RAS, the increase of CODMn in the water body favors bacterial growth, increasing the oxygen consumption rate and thereby adding costs. As a sewage filtration pretreatment technology, the EC–filtration system can remove CODMn from wastewater by electro-oxidation and flocculation–filtration, which have a better removal effect on CODMn

than traditional physical filtering methods.
Figure 3(c) shows the effect of different composite anodes and HRTs on CODMn removal in the EC reactor. The removal efficiency increased with the addition of the Fe electrode proportion to composite anodes and with the increase of HRT. Figure 3(d1)–3(d3) show the effects of different composite anodes and filter pore sizes on CODMn removal in the EC–filtration system. Removal efficiency increased by 14.73 times, 8.78 times, 6.56 times, and 5.39 times compared to the control group. Therefore, the EC–filtration system has an excellent removal effect on CODMn in aquaculture wastewater, and without changing the original filter aperture, EC can immensely enhance the capacity of the physical filtration equipment to remove CODMn.
Effects of the EC-filtration system on TAN, NO-2-N, NO-3-N and TN removal EC–filtration technology can remove TAN, NO-2N and NO-3N at the same time as removing residual bait and feces. Applying EC as a pretreatment process can not only reduce the load of subsequent biological oxidation equipment, but also improve the activity of microorganisms, thereby improving the
nitrogen removal capacity of RAS and reducing the threat of nitrogen pollutants to cultured organisms.
The application of composite anodes in the pretreatment of aquaculture wastewater through the EC–filtration system was evaluated in terms of electric energy loss. From Table 1, results show that during the EC process, the energy consumption of the system increased with the addition of the Fe electrode proportion to the composite anodes and with the increase in the HRT of the EC reactor. The study found that the electro-oxidation of the EC reactor was stronger when Fe was used as anode than when Al was used.

EC process could enhance the capacity of the subsequent physical filtration equipment. The EC–filtration system was found effective for the removal of the total number of Vibrio , CODMn, TAN, NO2N, NO 3-N and TN in aquaculture wastewater.
Compared with the Al electrode, when the Fe electrode was used as anode, the EC–filtration system had a stronger electro-oxidation capacity, which was conducive to the removal of TAN and NO-2-N. However, the
Applying electrocoagulation as a pretreatment process can not only reduce the load of subsequent biological oxidation equipment, but also improve the activity of microorganisms, thereby improving the nitrogen removal capacity of RAS and reducing the threat of nitrogen pollutants to cultured organisms.
flocculation effect was relatively weaker and the energy consumption was increased by 2.59 times. In comparison with the single Al or Fe anode, the Al-Fe combined anode had more advantages. Considering both removal efficiency and energy consumption, the optimum anode combination for the EC–filtration system was 3Al + Fe.
With the increase of HRT and the decrease of filtration pore size, the enhanced effect of the EC process on the filtration equipment was more obvious. When the HRT was 4.5 min and the filter pore size was 45 μm, the maximum removal efficiency for Vibrio , CODMn and TN increased by 3.31, 5.39 and 4.57 times compared with the control group, respectively.
This is a summarized version developed by the editorial team of Aquaculture Magazine based on the review article titled “APPLICATION OF HYBRID ELECTROCOAGULATION-FILTRATION METHODS IN THE PRETREATMENT OF MARINE AQUACULTURE WASTEWATER” developed by: JIANPING XU*, YISHUAI DU, TIANLONG QIU, LI ZHOU, YE LI*, FUDI CHEN* and JIANMING SUN- Institute of Oceanology, Qingdao and *University of Chinese Academy of Sciences. The original article, including tables and figures, was published on MARCH, 2021, through WATER SCIENCE & TECHNOLOGY. The full version can be accessed online through this link: doi: 10.2166/wst.2021.044
Shrimp has been recognized as the second most traded aquaculture products for decades. However, shrimp production in major producing countries has declined, mostly due to disease problem. Here we present a study aimed to determine the effect of dietary mannan oligosaccharides delivered through Artemia sp on the survival, growth, immunity, digestive enzymes and resistance against Vibrio harveyi of Pacific white shrimp larvae.
By: Aquaculture Magazine Editorial Team*Shrimp has been recognized as the second most traded aquaculture products for decades.

During the recent years, however, shrimp production in major producing countries has declined, mostly due to disease problem (FAO, 2016). Stentiford et al. (2017) recently reported that infectious diseases have caused shrimp industry to suffer devastating economics and social impacts with total losses exceeding 40% of global capacity. Amongst the efforts have been done to alleviate this problem, avoidance of disease outbreaks by management of pond and animal microbiomes remains to be the most
feasible approach to mitigate losses rather than attempting to eliminate the presence of pathogens. In this regard, the strategies to address disease problems in shrimp production have been directed toward improving the culture environment and enhancing the cultured animal’s strength and defense against disease infection. The later include improvement of the animal’s health status by supplying sufficient nutrients to support good growth and robustness, applying vaccination and immunostimulation to improve immunity and conditioning the animal’s microbiome by probiotics and prebiotics application.
Mannan oligosaccharides (MOS) are one of the prebiotics groups that have been gaining attention for the application in aquaculture, which are glucomannoprotein complexes derived from the cell wall of yeast, Saccharomyces cereviceae. Some beneficial effects of MOS have been recorded so far include enhancing health and growth performance improving gut morphology and microbiota, increasing immunity against disease; and robustness against stress.
Despite the growing evidence of prebiotic beneficial effects on the growth, survival and immune response of various aquaculture spe-
cies, there are only few studies have been done to explore the effects of prebiotic encapsulation in live food on the larviculture of aquaculture species. This study used Artemia to facilitate the delivery of MOS to the larvae, as it is the most common live food used in shrimp hatchery, which has a compatible size and nutritionally adequate for the larvae.

This study aimed to determine the effect of dietary mannan oligosaccharides (MOS) delivered through Artemia sp at different concentrations (i.e. 0, 3, 6 and 12 mg L-1) on the survival, growth, immunity, digestive enzymes and resistance against Vibrio harveyi of Pacific white shrimp larvae in four treatment groups (in triplicates), i.e. control, MOS3, MOS6 and MOS12. Larvae were reared in tank with a dimension of 25 cm × 20 cm × 30 cm containing 4 L of disinfected seawater at a stocking density of 30 larvae L-1. The larvae were maintained until they reached post larval stage for 15 days and were subsequently challenged with V. harveyi (107 CFU mL-1) for 5 days.

Artemia enrichment was performed following the procedures described by Daniels et al. (2010) with some modifications. Artemia naupli was obtained by hatching 2 g of Artemia cyst (Supreme Plus, US) in 1 L of seawater. Enrichment was performed by adding MOS (BIOMOS, Altech Inc., KY USA) into newly hatched Artemia nauplii culture medium (seawater at a salinity of 30 gL-1) at a concentration depending on the treatment. Artemia nauplii were maintained in prebiotic suspension at a density of 100 individual mL-1 for 4 h. Similar procedure was applied to Artemia nauplii provided for the shrimp in control treatment, except there was no prebiotic added to the Artemia cul-
ture medium. The nauplii were subsequently collected using a plankton net, rinsed with fresh seawater and directly transferred to the shrimp larvae culture tank or kept in a refrigerator (4°C) for later feeding time that day. Shrimp survival, growth, digestive enzymes activities, bacterial count, immune parameters were determined at the final day of experimentation. Shrimp survival was the proportion of survived shrimp at the end of the experiment over the initial number of shrimp at the beginning of the experiment.
Upon the completion of the feeding experiment, challenge test was performed using pathogenic Vibrio harveyi MR5339 isolated from shrimp infected with luminescent vibriosis (a collection of the Fish Health Laboratory of the Department of Aquaculture, Bogor Agricultural University). Challenge test was carried out on 10 shrimp from each replicate tank placed 15 units of glass container previously filled with 1 L of disinfected seawater. The bacterial suspension was added to each container at an initial density of 107 CFU mL-1 .
On the following day, V. harveyi suspension was occasionally added to replace loss due to water replacements,
which were done on day 1 and 3 of the challenge test period. Feeding during challenge test was done using non-enriched Artemia nauplii, which was offered five times a day. Negative control using the shrimp from the control treatment was applied in this test with similar treatment, except no V. harveyi suspension was added to the container. Challenge test was performed for 5 days.
Immune parameters were measured after feeding experiment (prior to challenge test) and after the completion of challenge test. Body fluid collection was conducted following the procedures previously described in Tampangallo, Pakidi, and Rantetondok (2012) with some modifications. Briefly, about 0.3 g of larvae (five to six post larvae) were collected from each replicate tank, placed in a pestle and added with 900 μL of precooled anticoagulant solution. Thereafter, each larva was slightly compressed to let the haemolymph flowing out the shrimp’s body and got mixed with anticoagulant solution.
The highest shrimp survival was observed in MOS12 treatment, which
was significantly different from other treatment groups (p < 0.05). MOS administrations on shrimp larvae resulted in higher growth as indicated by the significantly higher SGR and shrimp final length (Table 1, p < 0.05). The highest growth was observed in shrimp in MOS12 treatment.

The digestive enzyme activities in shrimp larvae fed with MOS were higher than those in the control group (Table 2). Furthermore, the increase of digestive enzyme activity was positively correlated with the increase of MOS concentrations with correlation coefficients for protease, lipase and amylase were 0.96, 0.95 and 0.91, respectively (p < 0.05). The ratio of RNA/DNA in shrimp with treatment MOS6 and MOS12 were significantly higher than those with the control and MOS3 treatment (p < 0.05) (Figure 1).
After feeding experiment, the immune parameters in treatments with MOS were evidently improved, with the levels increased with the increase of MOS concentrations (Table 3).

After challenge test, decreases in all immune parameters were observed compared to those before challenge test. However, the shrimp immune parameters before and after challenge test showed similar trends, where shrimp fed with MOS-encapsulated Artemia nauplii showed higher levels of immune responses (Table 4). This was confirmed by the higher number of shrimp survivors in MOS treatments than that of the positive control following challenge test against V. harveyi (Figure 2).
To date, most of MOS or other prebiotics studies were performed in juvenile or adult (grow out) stage and only limited information is avail-

able on their application in larvae production of aquaculture species. Thereby more research is needed to fully comprehend the efficacy of dietary prebiotics in crustacean larvae production. The application of MOS on crustacean larvae production has been reported so far was done by Daniels et al. (2010; 2013) who demonstrated the positive effects of MOS-enriched Artemia on the growth and immunity of European lobster postlarvae.
The present study demonstrated that MOS encapsulation using Artemia nauplii positively affected the growth performance of shrimp larvae. Although the differences between MOS3 and MOS6 treatments were not significant, it was generally shown that the increase of prebiotic concentrations was concomitant with the increase of shrimp specific growth rate and final total length. Furthermore, the differences in growth potential of the shrimp post
larvae amongst the treatments were also demonstrated by the levels of RNA/DNA ratio as an indicator of protein synthesis (Li et al., 2013). The positive effects of MOS in improving growth performance were consistent with previous study by Zhang et al. (2012) on Pacific white shrimp juveniles.
The underlying modes of actions of dietary MOS on the animal’s growth have been reported to this point mostly relates to: 1) the improvement of gut morphology and functionality, i.e. increase of microvilli length and density, higher number of goblet cells, higher production of intestinal mucus, which may facilitate higher capacity for nutrient digestions and absorptions in the animal’s intestine (Sang et al., 2011a; Zhang et al., 2014), 2) the facilitation of beneficial microbiota in the animal’s gastrointestinal tract (GIT) that may contribute to the excretion of digestive enzymes and to the alteration in host’s nutrients metabolism; 3) the improvement of feed intake by contributing in satiation and appetite signals and regulations (Torrecillas et al., 2014).
Indeed, this study demonstrated that dietary supplementation of MOS could improve the activity of main digestive enzymes, i.e. protease, lipase and amylase, which may contribute
to the increase capacity of nutrient digestion and ultimately resulted in better growth of the shrimp postlarvae. Previous studies showed that the effect of MOS on digestive enzymes might be different between species or between developmental stages. Sang et al. (2011a) showed that MOS could improve the digestive enzyme activity in hepatopancreas and midgut of yabbies (Cherax destructor), thus increasing the bioavailability of nutrients in the diet. However, further study is needed to elucidate the role of prebiotics on the digestive enzyme activity.

The enhanced shrimp survival in MOS treatments might be explained by the enhanced shrimp robustness against stress and immunity against possible disease infection. Indeed, the results showed that following 15 days of dietary MOS treatments, the shrimp total haemocyte count, phagocytic and PO activities and respiratory burst were significantly enhanced. These results confirmed previous study showing that dietary administration of MOS on Pacific white shrimp juvenile resulted in enhanced the shrimp antioxidative capacity and immunocompetence as well as its robustness against ammonia exposure stress. It is even interesting to note that the shrimp survival in treatment MOS12 was not
significantly different to that of the negative control and that the immune parameters in the after challenge test were still significantly higher in MOS treatments than those of the control indicating the higher defense capacity of the animals against the disease.
Along with the immune system stimulating effects, MOS may also play an important role in blocking pathogen colonization in the animal’s GIT. Torrecillas et al. (2014) suggested that MOS protection against disease outbreaks maybe associated to the promotion of gut pre-epithelial defense mechanism, i.e. by increasing intestinal goblet cells density and mucus production in the intestinal tract. It has been suggested that mannose could be used as inhibitors of pathogen adhesion to intestinal cells. Pathogenic bacteria may recognize and adhere to mannan that mimics the specific carbohydrates groups of intestinal cells. As MOS is not digested, it will be removed with the feces and therefore reducing the incidence of the potential disease.
In conclusion, the study demonstrated that MOS administration through bioencapsulation in Artemia nauplii at the concentration up to 12 mg MOS L-1 could improve the digestive capacity, growth, survival and immunity of Pacific white shrimp post larvae against V. harveyi infection.
This is a summarized version developed by the editorial team of Aquaculture Magazine based on the review article titled “DIETARY MANNAN OLIGOSACCHARIDES POSITIVELY AFFECT THE GROWTH, DIGESTIVE ENZYME ACTIVITY, IMMUNITY AND RESISTANCE AGAINST VIBRIO HARVEYI OF PACIFIC WHITE SHRIMP (LITOPENAEUS VANNAMEI) LARVAE” developed by: WIDANARNI, ABDURAHMAN TAUFIK, MUNTI YUHANA and JULIE EKASARI - Bogor Agricultural University, Department of Aquaculture, Faculty of Fisheries and Marine Science. The original article, including tables and figures, was published on ABRIL 2018 through Turkish Journal of Fisheries and Aquatic Sciences. The full version can be accessed online through this link: http://doi. org/10.4194/1303-2712-v19_4_01
Indonesia itself has the largest aquaculture production potential in the world. Based on data from the Ministry of Maritime Affairs and Fisheries (2021), since 2010 aquaculture production, has exceeded capture fisheries production. Until 2019, aquaculture contributed about 68.4% of Indonesia’s total fishery production, with an average growth of 16% per year during 2000-2019.
By: Angkasa Putra*Indonesia with a strategic geographical position is the largest archipelagic state in the world. The number of islands in Indonesia officially recorded has reached 16,056 islands as determined at the United Nations Conferences on the Standardization of Geographical Names (UNCSGN) and United Nations Group of Experts on Geographical Names (UNGEGN) forums (7-18 August 2017) in New York, United States of America. In another reference (Hargo, 2017) it is stated that based on the identification results
there are 17,508 islands throughout Indonesia (7,353 named islands and 10,155 unnamed islands) and of the 7,353 named islands, there are 67 islands directly bordering neighboring countries. The coastline of Indonesia is 99,093 km2 (BIG, 2017), the second in the world after Canada. Its land area reaches about 2,012 million km2 and the sea is about 5.8 million km2 (75.7%), 2.7 million square kilometers of which are included in the Exclusive Economic Zone (EEZ) (Ramadhan & Arifin, 2013). It has 275.77 million people (as of the middle of this year based on BPS, 2022) where most of them live in coastal
areas. State control over Indonesia’s seas needs to be balanced between ecological, economic, and social sustainability.
Several references state that Indonesia is already ranked among the most productive countries in aquaculture production. Aquaculture has an important role in the development of many national economies and plays a key role in rural development. In the definition provided by the FAO, aquaculture is the cultivation of aquatic organisms including fish, mollusk, crustaceans, and aquatic plants. This

field implies some kind of intervention in the rearing process to increase production, such as regular stocking, feeding, or protection from predators. Also implies individual or corporate ownership of the shares being processed. Further, aquaculture is the aquatic partner of agriculture; it has developed rapidly in recent decades.
Aquaculture is the primary means of obtaining more food from our aquatic environment in the future. The impact of aquaculture on biodiversity arises from the consumption of resources, such as soil (or space), water, seeds, and feed, their transformation into products valued by society, and their subsequent release into the environment of greenhouse gases and waste from uneaten food, feces, and urinary products, chemotherapy as well as microorganisms, parasites, and wild animals.
On the one hand, aquaculture is an economic activity that uses and converts natural water resources into commodities that are valued by society and thus can have an impact on biodiversity, basically due to resource consumption, the process of its own transformation, and the production of waste.
Global marine capture fisheries production has stagnated (leveling-off), around 90 million tons/year, since the late 1990s (FAO, 2022). In addition, the development of livestock and agriculture is also constrained by conversion of agricultural land to other land uses, pollution, environmental degradation of terrestrial ecosystems, and social conflicts.
Indonesia itself has the largest aquaculture production potential in the world. Based on data from the Ministry of Maritime Affairs and Fisheries (2021), since 2010 aquaculture production, has exceeded capture fisheries production. Until 2019, aquaculture contributed about 68.4% of Indonesia’s total fishery production, with an average growth of 16% per year during 2000-2019. In the
previous data, aquaculture production increased from 994,962 tons (2000) to 1.4 million tons (2004) or increased at a rate of 10.36 percent per year (Central Research Institute for Aquaculture).
On the one side, since 2009 Indonesia has become the 2nd largest aquaculture producer in the world, as well as in 2019 according to FAO (2021) regarding the top 10 Global Aquaculture Producers in 2019 with a value of 15,893,400 tons; 13.23%, after China which is in first place (68,423,859 tons; 56.97%), and In-
dia in third place (7,800,300 tons; 6.49%). Furthermore, related to Indonesian Aquaculture Production data based on Main Commodities from 2016 to 2020 (tons) (Source: Data of Ministry of Marine Affairs and Fisheries of the Republic of Indonesia), the following data are presented (Table 1).
Then, the projection of Indonesian Aquaculture Production 20202024 (tons) based on data from the Ministry of Marine Affairs and Fisheries of the Republic of Indonesia in 2021 can be seen in the Table 2.


It can be concluded that aquaculture is Indonesia’s mainstay in the Marine and Fisheries Sector and globally in the Maritime Sector.
Furthermore, Ministry of Marine Affairs and Fisheries of the Republic of Indonesia data (2022) shows that the potential land for Indonesian aquaculture for seawater cultivation is about 12.1 million hectares, brackish water cultivation is about 2.9 million hectares and fresh water cultivation is about 2.8 million hectares. And targeted this year: Fish: 7.35 million tons, Shrimp: 1.34 million tons, Ornamental Fish: 2.1 million fish, Seaweed: 11.85 million tons, Revenue: 3.55 miles/month, and Fish Farmer Exchange Index: 103. So it can be concluded that aquaculture is Indonesia’s mainstay in the Marine and Fisheries Sector and globally in the Maritime Sector. With a note, productivity must be increased, be responsible, environmentally friendly, and also sustainable.
In other research results, for example from WorldFish (2019), it is stated that looking at the current value of aquaculture production can be a reference so that an estimate of the contribution to each product group throughout the Indonesian archi-


pelago and its ecological status can be made. In the following, research data from WorldFish is presented by looking at the potential for aquaculture interventions and innovations in several categories that will enable the aquaculture sector to grow without compromising the environment. Growing the aquaculture sector without causing negative effects on the environment is a noble goal. This can be realized through the implementation of sustainable cultivation practices that do not endanger the function of coastal ecosystems. More commonly known as blue economy. Furthermore, if the implementation of sustainable aquaculture can be realized, then fundamentally contribute to the welfare of the Indonesian people by offering an affordable source of nutritious animal protein.
Moreover, the Indonesian government has set ambitious targets for aquaculture growth by 2030 one of the goals is to combat high rates of malnutrition and stunting.
 By: Aquaculture Magazine Editorial Team*
By: Aquaculture Magazine Editorial Team*
Focusing on the role of youth in the development of aquaculture, the Aquafest IPB 2022 Student Conference was held according to the theme, “The Role of Students in Aquaculture Development”. Three topics were discussed, namely the development of aquaculture technology applied by each group of countries, impacts or problems arising from the aquaculture technology that has been applied, and solutions to said problems from each delegations perspective.
The result of the discussion is the participants had a good level of knowledge about the world of aquaculture. This shows that every country has an increasing level of education. As well as assistance from teachers who have provided perspectives to the participants. It should be realized that when talking about cultivation systems, there are several things that must be highlighted and need to be developed. Such as technology, impact, and solutions to existing problems. Geographical conditions also affect aspects of cultivation. One thing that gives each
Focusing on the role of youth in the development of aquaculture, the Aquafest IPB 2022 Student Conference was held according to the theme, “The Role of
country an impression is the application of different technologies. Not only that, there are several countries that also receive support from other countries. This shows that the private sector also provides support for the advancement of cultivation technology. However, there are problems in some countries, namely that some cultivating countries find it difficult to use technology.
Like the representative of the Indonesian aquaponics system. As populations continue to increase and the
threat of food insecurity increases, aquaponics is a promising technology for producing high quality fish and vegetable protein in a way that uses less land, less energy and less water while also using chemicals.
In the results of the conference that was contested, there were 2 winners at ASC, namely the best delegate category and the best opinion category. The best delegation was won by Zoren Francis Acebuque Echevarria from the Philippines delegation as the first winner, Muhammad Firman Nuruddin from Indonesia as the second winner, and Qurrotu Aini Syafaq from Indonesia as the third winner. Next is the winner of the best opinion. The best opinion was won by Ruby Agil Hasan from Indonesia, then the second winner from Indonesia, namely Bela Rahma Sayida, and Syifa Nuzullia Salsabiil from Indonesia as the third winner.
From this activity, participants are expected to be able to provide ideas to solve problems that exist in each country and develop existing technologies in cultivation.

Students in Aquaculture Development”
It appears that many in the field that advocate the control of vibrios either in the environment or through the gut do not understand the concept of “viable but nonculturable” (VBNC). This is not a new idea although we continue to learn more about it.
The widespread dogmatic approach towards shrimp culture dictates that certain bacteria pose problems simply by being present. These are the vibrios. Vibrios are ubiquitous bacteria in most marine environments. They are highly evolved and can grow under a variety of conditions. A few of them are opportunistic pathogens of fish and shrimp and a few are well known pathogens of humans ( V. cholerae and V. parahaemolyticus ). For shrimp most are what are termed opportunistic pathogens. The host must be weakened in some manner for the specific species/strains to cause pathology. There are many other bacteria that have been associated with disease in farmed shrimp that are largely ignored. Most are opportunistic although will cause disease in healthy

animals, termed obligate pathogens.
Many companies appear to be offering approaches to a problem that in reality is not a problem. Healthy strong animals in stress-free environments are not bothered by most vibrios. Only a few are obligate pathogens and there is some justification for attempting to control the levels of them. Notably the strains of V. parahaemolyticus that produces PIRa and PIRb and T6SS (type 6 secretory systems that allow the vibrio to kill other bacteria). This strain is unique in many respects with the evidence strongly suggesting that it dominates in environments where efforts have been made to eliminate bacteria and other potential pathogens through the use of chlorine. Selective elimination of vibrios that are incapable of degrading the sugar, sucrose and thus appearing green on the selective
media, TCBS is more than likely not helpful in the long run. There are species that are capable of degrading the sugar that are highly virulent obligate pathogens their colonies are yellow on TCBS.
Farmers are much better off minimizing the stressors that are present via proactive management strategies including but not limited to adequate levels of aeration at all times, the use of automatic feeders to reduce waste and lessen competitive stress, and bioremediation to lessen the food available for potential pathogens than trying to selectively eliminate one species of bacteria. Genetic selection can also play a role in reducing the overall susceptibility to common stressors.
It appears that many in the field that advocate the control of vibrios either in the environment or through
the gut do not understand the concept of VBNC. This is not a new idea although we continue to learn more about it. The acronym stands for “viable but nonculturable”. It means what it says; bacteria are viable but cannot be cultured. This is actually fairly common, and the vibrios are not the only taxon that this applies to. Conditions that appear to be sufficient to kill a specific group of bacteria turn out to be at best temporary. The bacteria are injured and cannot be cultured yet they are still metabolically active to some extent and may in some instances continue to produce toxins. Once the insult is no longer present, they can revert to their prior status, becoming metabolically active and being culturable. Any effort to culture the bacteria will be fruitless until they have recovered sufficiently.
Strategies that are aimed at eliminating vibrios, whether it is through the use of chlorine, the use of antibiotics, whether man made or produced by competitive species of bacteria, and the use of compounds in the feed to inhibit bacteria in the gut that do not take this into account are prone to failure. Elimination of large swatches of potentially “bad” bacteria is not necessarily the best approach to take. The data strongly suggests that with EMS or AHPNS that we are creating an environment that allows the etiologic agent to proliferate at the expense of other bacteria. By treating ponds with chlorine in a misguided attempt to kill off all possible pathogens it appears that we are making it easier for these strains to proliferate at the expense of whatever bacteria might still be present. When we look for

them via culture, we may not find them yet there can be tell-tale signs that they are present, specifically the presence of the toxins that are pathognomic.
Manipulation of the microbiome is a relatively recent concept and there are any numbers of publications that purport to demonstrate that certain disease states are a result of alterations in the microbiome and that these changes are predictive. The tools used are based on the detection of specific genes. It does not make a distinction between living and VBNC bacteria. VBNC can still be actively synthesizing proteins.
Even though we have known about this state for almost 40 years, there are still many unanswered questions. Many different factors have been identified for various species that induce the VNBC state and
many more are likely to be found. The use of culture to validate the effectiveness of any number of feed additives should be viewed with caution. Often these damaged bacteria when removed from the immediate environment where they are declared dead because they cannot be grown up on or in bacteriological media will revert to being culturable.
They are also capable of producing toxins when they are in the VNBC state. This could explain why there are instances with the strain of VP that is responsible for EMS or AHPNS where the etiologic agent cannot be cultured. Enriching samples by adding them to culture media and incubating them for 18 to 24 hours can reveal that there are viable cells present. This should not be taken to mean that there are not
instances when the application of disinfectants and/or compounds in the feed is in fact effective at killing them. There are instances where the data regarding the use of disinfectants or compounds in the feed (such as organic acids) should be viewed from the standpoint that the VNBC state is why they cannot be cultured on agar plates and not due to the treatment.
Care should be taken in experimental design to ensure that not only are there appropriate controls but specific properties, such as VNBC, are taken into account. Concluding that a given modality results in killing bacteria when in fact they have become VBNC can lead to misleading claims and the use of products that do not do the job that the end users believe that they need.
Once the insult is no longer present, they can revert to their prior status, becoming metabolically active and being culturable.
Stephen G. Newman has a bachelor’s degree from the University of Maryland in Conservation and Resource Management (ecology) and a Ph.D. from the University of Miami, in Marine Microbiology.
He has over 40 years of experience working within a range of topics and approaches on aquaculture such as water quality, animal health, biosecurity with special focus on shrimp and salmonids. He founded Aquaintech in 1996 and continues to be CEO of this company to the present day. It is heavily focused on providing consulting services around the world on microbial technologies and biosecurity issues. sgnewm@aqua-in-tech.com www.aqua-in-tech.com www.bioremediationaquaculture.com www.sustainablegreenaquaculture.com


The Fishmonger has been looking at other protein markets to consider what they are doing in this space and has concluded that working on your brand will create dividends well into the future.
The time and money that continues to be spent on “private” accreditation/certification is not a worthwhile investment for anyone in our industry long term. Eventually governments will create simple entry levels for all aquaculture production – it has done this for food safety for many years. These entry levels will cover animal welfare, traceability, environmental sustainability, and other such relevant issues. They will be mandatory so there will be no need for the costly certification/accreditation programs which have become major businesses in their own right over the years.
As and when this occurs producers will be looking towards “what makes them different” and that will then highlight the need for branding more than ever. Branded product will be secret to price premiums.
Major market buyers will expect exemplary animal welfare and sustainable practices as they have with food safety. This will be the “ticket to play” and access markets but if all produc-
The Fishmonger has been looking at other protein markets to consider what they are doing in this space and has concluded that working on your brand will create dividends well into the future.

ers are in that space, then when is your point of difference? If you do not have one, then you are back in the commodity arena and will just be a price taker. If you make your brand stand out, creating a premium product you will be a price maker and that will be how you forget your future.
Does anyone really think that consumers pay extra for food safety? Of course not! It is a given naturally and following up from there you have to seriously doubt that consumers would be prepared to pay any premiums for animal welfare, among other, because it will become expected behavior. No question the alternatives present far too many risks to the industry.
Now the certification/accreditation companies will always prepare surveys that will tell you differently and why not? It is in their interests to do this. Over the years they have cleverly created a massive business positioning between the producers and major buyers continually manipulating positions to suit. Good knowledge has been gained which clearly has been beneficial but there are simply far too many organizations in this space, they all work to different standards, and this has created so much confusion for the end users. No one is getting premiums for product meeting these criteria and those governing organizations have no concerns for producers in this regard.
You can create your own surveys or better still engage with your direct end users, and you will get a far better idea on where people stand on these
issues enabling you to better plan for your future. After all you are no longer selling what you have but what the consumers want.
The risks with producing aquaculture are already at the top end and no matter where you are this is a prohibitive cost industry. Once product has been produced you need some surety of market and price and what the certification is giving you are extra costs, locking you into commodity pricing and no individual opportunity to highlight your point of difference.
Consider looking at products like eggs. There is a baseline standard for eggs and there are many different offerings. There are premiums being obtained for free range over caged as example. Many companies have seen this as an opportunity to create their own brand and have built a story around obtaining a premium price for a premium product. The difference can be dollars per dozen in the egg business and there is no reason this cannot be the same with aquaculture products.
This concept is further advanced in two other areas that The Fishmonger is aware of. The first is “Label Rouge” (Red Label), a French government controlled sign of quality assurance defined by Law No. 2006-11. According to the French Ministry of Agriculture: “The Red Label certifies that a product has a specific set of characteristics that establish a higher level that a similar current product”.
The first aquaculture fish endorsed, it is reported, was in 1992, when Scottish salmon was awarded the Label Rouge quality mark, the official endorsement by the French authorities of the superior quality of a food or farmed product, particularly with regard to taste.
al is officially announced through a joint decree from the French Minister for Agriculture and Fisheries and the French Minister for Consumer Affairs, on the recommendations of the National Institute for Origin and Quality (INAO). INAO is the French public body responsible for quality and origin marks relating to food products.
Scottish Quality Salmon is the standard owner of Label Rouge No. LA 33/90. Compliance with the standards is controlled by an independent certifying body, Acoura, formerly Food Certification International Ltd. Suppliers of whole Label Rouge Scottish salmon and Label Rouge Scottish salmon portions can be found on the Label Rouge Saumon Ecossais website (Home - Label Rouge Scottish Salmon (saumonecossais.com).
The other area is in Australia through the Sydney Royal Aquaculture competition. This competition goes back to 1870 when only smoked, dried and preserved fish were exhibited, but today the competition includes cooked prawns, oysters, fresh fish, cured salmon/trout, caviar, and other farmed aquaculture products from all over Australia.
Branded product will be secret to price premiums.
To obtain this recognition, a very stringent set of standards prepared by a group of producers must be approved. These standards establish the criteria which the product must meet throughout the production chain, including farming techniques, feed, processing, and distribution. Approv-
The object is not to judge one product against another or one producer against another but to benchmark all entered products against criteria based on taste and looks organized around consumers requirements. Essentially Sydney Royal Competitions set the benchmark for agricultural excellence that underpins Australia’s agricultural performance
The Fishmonger encourages you all to create your values that appeal to your consumers.
After all you are no longer selling what you have but what the consumers want.
ensuring a viable and prosperous future for our rural communities.
Medals are awarded based on blind independent judgements; a win is testament of achievement at the highest level. It is recognition of dedication, ability, uncompromising diligence, and sheer arduous work.
As well as pride and prestige, a Sydney Royal win provides a springboard to increase returns. All winners receive Sydney Royal medal or trophy artwork designed to be used across a wide range of marketing collateral.
Regardless of a win in the Wine, Dairy and Fine Food competition, judges’ comments are made available to every exhibitor enabling them to improve the quality of their livestock, agricultural produce, or product. All Sydney Royal Competitions, even those not connected directly to the land, are geared toward promoting, fostering, and encouraging the sustainable development of rural communities and agriculture in Australia.
This is great for all sized operations, but it is especially good for smaller producers as they get the opportunity to benchmark their products annually without much cost and, if successful, get incredible publicity which clearly adds value to their product. Additionally high level restaurants are always on the lookout for a point of difference in supply sources and there is evidence that they pay premiums for that.
Recently Rabobank (Dutch multinational agri-banking and financial services company) issued their latest report, “Global Seafood Trade: The Decade’s Winners Grow in Influence,” (released 13 October) highlighted premium aquaculture –in particular, salmon and shrimp– has been a driving force behind current growth.
This report suggested that the United States’ seafood market has fully recovered from the COVID-19 pandemic and is now the world’s fastest-growing market for seafood imports, with imports valued at USD 28 billion (EUR 28.9 billion) last year.
Importantly, it noted, that the demand is being driven by health- and sustainability-conscious consumers, particularly among millennials and baby boomers, with millennials accounting for more than USD 200 billion (EUR 206.1 billion) in purchasing power, and the latter demographic comprising seventy-seven million people.
So, The Fishmonger encourages you all to create your values that appeal to your consumers; build your story around those; take advantage of benchmarking your product and enhancing your quality. Bring your staff

with you on this journey and get everyone involved and you will be surprised what benefits come your way.
France acts on “Meat”
It has taken some time but finally the penny has dropped in France and that hopefully will flow on right around the world. Plant based products will no longer be able to be labelled “Meat”!
The decree issued in the French government gazette, Journal official states: “It will no longer be possible
to use terminology belonging to sectors traditionally associated with meat and fish to describe products that do not come from animals.”
This will include terms such as “steak,” “lardons” or “sausage”, to describe plant-based products that are considered as meat substitutes.
This rule came into effect on 1 October 2022. Products made and labelled before this date will be permitted to remain on sale until 31 December 2022.
The decree lays out precise rules for the amount of vegetable protein allowed in meat products for them
to be able to keep their “meat”-relayed names, for products that come from animals but have some vegetable protein. An example given was hamburger (minced meat) may continue to carry a “steak hache” label provided that its vegetable protein content does not exceed 7%. This percentage drops to 3% for frankfurters, 1% for black pudding or dry sausage, and 0.5% for bacon.

Some farmers’ groups in France say the decree does not go far enough but everyone agreed that it is a good start and should be extended throughout Europe and beyond.
Terms like “milk”, “butter” and “cheese” are already banned at the European level on products that are not of animal origin.
Interestingly the term “burger” used by many brands to attract customers, would still be allowed as it does not specifically refer to meat.
Does anyone really think that consumers pay extra for food safety? Of course not!
WORLD AQUACULTURE SINGAPORE 2022
Nov. 29-Dec. 2, 2022
Singapore.
T: (+1) 760.751.5005 FAX (+1) 760.751.5003
E: worldaqua@was.org W: www.was.org
CONGRESO DE ACUACULTURA DE CAMARÓN CONACUA 2022
Nov. 30 y Dic. 1, 2022
Los Monchis, Sinaloa, México.
T: 668 103 0484 – 668 815 6227 – 555 563 4600
E: organizacionconacua@gmail.com
W: www.conacua.com
JANUARY 2023
AQUACULTURE AND AQUAPONICS TRAINING FOR FOOD SECURITY AND CLIMATE RESILIENCE 2022-2023
Nov 2022 – Feb 2023
La Paz, BCS, México.
E: talleres.acuaponia@cibnor.mx
W: https://www.cibnor.gob.mx/eventos-cibnor/3319-aquacultureand-aquaponics-training-for-food-security-and-climateresilience-2022-2023
FEBRUARY 2023
AQUAEXPO 2023, SANTA ELENA FEB 8-9, 2023
Ecuador
T: +593 4 268 3017 ext.124 y 130
E: cjauregui@cna-ecuador.com cmosquera@cna-ecuador.com W: https://aquaexpo.com.ec/santaelena/
SEAGRICULTURE CONFERENCE ASIA-PACIFIC 2023
FEB 8-9, 2023 (OnLine)
T: +31 85 401 73 97
E: info@dlg-benelux.com
W: https://seagriculture-asiapacific.com/
AQUAFARM
FEB 15-16, 2023
Pordenone, Italia T: +45 70 22 19 10
W: www.aller-aqua.com/es/eventos/aquafarm-15-16-de-febrerode-2023
AQUACULTURE AMERICA 2023
FEB 23-26, 2023
New Orleans, USA
T: (+1) 760.751.5005 FAX (+1) 760.751.5003
E: worldaqua@was.org W: www.was.org
MARCH 2023
ACUICULTURA OFF-SHORE March 13-29, 2023
Islas Canarias, España T: +34 928 424 600
E: consultas@spegc.org W: https://www.spegc.org/formacion-y-eventos/acuicultura-offshore/
AQUASUR TECH 2023
MARCH 29-30, 2023
Punta Arenas, Chile
T: +569 81888565
E: info@aquasur.cl W: www.aquasurtech.cl/
APRIL 2023
LATIN AMERICAN & CARIBBEAN AQUACULTURE 2023 (LAQUA 2023) April 18-21, 2023
Panama City, Panama
T: (+1) 760.751.5005 FAX (+1) 760.751.5003
E: worldaqua@was.org y carolina@was.org W: www.was.org
AERATION EQUIPMENT, PUMPS, FILTERS AND MEASURING INSTRUMENTS, ETC
DELTA HYDRONICS LLC.................................................................9 T: 727 861 2421 www.deltahydro.com THE ROYAL VAN BEEST GROUP....................................................25 www.greenpin.com ANTIBIOTICS, PROBIOTICS AND FEED ADDITIVES
BAJA AGRO INTERNATIONAL......................................BACK COVER Privada Kino Este No. 100A-1 Parque Industrial Misión Ensenada, Baja California, Mexico CP 22830 www.yucca.com.mx
SÓMA..........................................................................................49 24, Hanbul-ro 69 Beon-gil, Eumseong-eup, Eumseong-gun, Chungcheongbuk-do 27698, Korea E-mail : somafeednadditive@gmail.com T: 043-878-0591 www.ssoma.co.kr
AQUACULTURE AMERICA 2023......................INSIDE BACK COVER
February, 23-26, 2023. New Orleans Marriott. New Orleans, Louisiana. Tel: +1 760 751 5005 E-mail: worldaqua@aol.com www.was.org
CONACUA 2022.............................................................................5
Novermber 30 - December 1st, 2022. Figlos Convention Lounge, Los Mochis, Sinaloa, México. Tel: 6681 030 484 / 6688156227 / 555 5634600 www.conacua.com
LACQUA 2023...........................................................INSIDE COVER April, 18 - 21, 2023.
Hotel Riu Plaza,Panama City, Panama. Tel: +1 760 751 5005 E-mail: worldaqua@aol.com www.was.org
REEFER CARGO
MSC..............................................................................................1
T: +52 55 5091 7070 www.msc.com/seafood
AQUACULTURE MAGAZINE
Design Publications International Inc. 401 E Sonterra Blvd. Sté. 375 San Antonio, TX. 78258, USA Office: +210 504 3642 Office in Mexico: +52(33) 8000 0578 - Ext: 8578
Subscriptions: iwantasubscription@dpinternationalinc.com Sales & Marketing Coordinator. Juan Carlos Elizalde crm@dpinternationalinc.com | Cell: +521 33 1466 0392
Sales Support Expert, Abril Fernández sse@dpinternationalinc.com | Cell:+521 333 968 8515
Empresarios No. #135 Int. Piso 7 Oficina 723 Col. Puerta de Hierro, C.P.45116 Zapopan, Jal. México Office: +52 (33) 8000 0578
Contact 1: Subscriptions E-mail: suscripciones@panoramaacuicola.com Office: +52 (33) 8000 0629 y (33) 8000 0653
Contact 2: Juan Carlos Elizalde, Sales & Marketing Coordinator. crm@dpinternationalinc.com | Cell: +521 33 1466 0392
Contact 3: Abril Fernández, Sales Support Expert E-mail: sse@dpinternationalinc.com www.panoramaacuicola.com



















